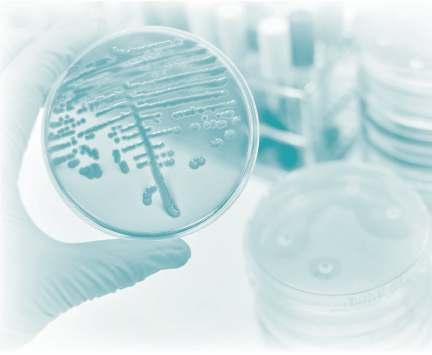
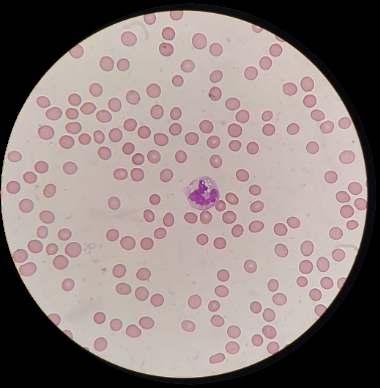

Síndrome de Ovario Poliquístico y la Resistencia a la Insulina

Enfermedad de Von Willebrand adquirida en un Mieloma múltiple: reporte de caso
![]()
Síndrome de Ovario Poliquístico y la Resistencia a la Insulina

Enfermedad de Von Willebrand adquirida en un Mieloma múltiple: reporte de caso
Dispositivo individual de un solo uso que contiene
todos los reactivos necesarios para realizar el ensa
Capacidad multiparamétrico: Procesa hasta 30 diferentes pruebas por corrida.
La velocidad permite obtener resultados simultáneos de diferentes paneles.
El primer resultado se obtiene antes de 90 minutos.
Volumen de muestra:
La muestra se dispensa manualmente ELISA:
Mínimo de muestra 60 uL.
Enfermedades Infecciosas
ADENOVIRUS IgA
ADENOVIRUS IgG
BORDETELLA PERTUSSIS IgA
BORRELIA IgG
BORRELIA IgM
BRUCELLA IgG
BRUCELLA IgM
CHIKUNGUNYA IgG
CHIKUNGUNYA IgM
CHLAMYDOPHILA PNEUMONIAE IgA
CHLAMYDOPHILA PNEUMONIAE IgG
CHLAMYDOPHILA PNEUMONIAE IgM
CLOSTRIDIUM DIFFICILE A/B TOXINS
CLOSTRIDIUM DIFFICILE GDH
COXACKIE VIRUS A MIX
COXACKIE VIRUS B MIX
CYTOMEGALOVIRUS IgG
CYTOMEGALOVIRUS IgG AVIDITY
CYTOMEGALOVIRUS IgM
DENGUE IgG
DENGUE IgM
DIPHTERIA IgG
ECHINOCOCCUS IgG
ECHO VIRUS N MIX
ECHO VIRUS P MIX



EPSTEIN-BARR EARLY ANTIGEN IgG
EPSTEIN-BARR EARLY ANTIGEN IgM
EPSTEIN-BARR EBNA IgG
EPSTEIN-BARRVCA IgG
EPSTEIN-BARR VCA IgM II
HELICOBACTER PYLORI IgA
HELICOBACTER PYLORI IgG
HSV1 SCREEN
HSV2 SCREEN
HERPES SIMPLEX 1 IgG Recombinant
HERPES SIMPLEX 1+2 IgM
HERPES SIMPLEX 2 IgG Recombinant
INFLUENZA A IgA
INFLUENZA A IgG
INFLUENZA B IgA
INFLUENZA B IgG
LEGIONELLA PNEUMOPHILA
LEGIONELLA PNEUMOPHILA 1 IgG
LEGIONELLA PNEUMOPHILA 1-6 IgG
LEGIONELLA PNEUMOPHILA IgM
LEGIONELLA URINARY ANTIGEN
LEPTOSPIRA MIX
LISTERIA MONOCYTOGENES
MEASLES IgG
MEASLES IgM

MUMPS IgG
MUMPS IgM
MYCOPLASMA PNEUMONIAE IgA
MYCOPLASMA PNEUMONIAE IgG
MYCOPLASMA PNEUMONIAE IgM
PARAINFLUENZA MIX
Parvovirus B19 IgG
Parvovirus B19 IgM
POLIOVIRUS IgG
Q FEVER
RESPIRATORY SYNCYTIAL IgA
RESPIRATORY SYNCYTIAL IgG
RUBELLA IgG AVIDITY
RUBELLA IgG
RUBELLA IgM
SYPHILIS SCREEN RECOMBINANT
TETANUS IgG
TICK-BORNE ENCEPHALITISVIRUS
TOXOPLASMA IgG
TOXOPLASMA IgM
TRACHOMATIS IgA
TRACHOMATIS IgG
TREPONEMA IgG
TREPONEMA IgM
VARICELLA IgG
VARICELLA IgM
25 OHVITAMIN DTOTAL
TICK-BORNE ENCEPHALITIS VIRUS IgM
TIROGLOBULIN HIGH SENSITIVITY
TOSCANAVIRUS IgG
TOSCANAVIRUS IgM
TOXOCARA IgG
TOXOPLASMA IgA
TOXOPLASMA IgG AVIDITY
ANA-8
ANA-SCREEN
ENA-6 S
SM
SS-A
SS-B
Scl-70
Cenp-B
Jo-1
ds-DNA-G
ds-DNA-M
snRNP-C
U1-70 RNP
anti-CCP
RF-G
RF-M
CALPROTECTIN
CALPROTECTIN K
CARDIOLIPIN-G
CARDIOLIPIN-M
BETA 2-GLYCOPROTEIN-G
BETA 2-GLYCOPROTEIN-M
DEAMIDATED GLIADIN-A
DEAMIDATED GLIADIN-G
GLIADIN-A




Editorial
Noviembre nos brinda una oportunidad para explorar avances médicos cruciales Este número presenta cinco artículos que abarcan desde innovaciones terapéuticas hasta nuevasestrategiasdediagnóstico.
En esta edición, un estudio destaca la subestimación del riesgo cardiovascular en obesos mórbidos y la importancia de la implementación de tratamientos preventivos para evitar complicacionesafuturo.
La prevención del Síndrome de Ovario Poliquístico es esencial para reducir el riesgo de complicaciones a largo plazo. Presentamos un estudio que establece la insulina libre como un biomarcador en el hirsutismo, resaltando la necesidad de un enfoquemultidisciplinarioypersonalizadoensutratamiento.
Uno de nuestros casos clínicos del mes describe Enfermedad de von Willebrand asociada al mieloma múltiple en unapacientefemeninasindiagnósticoprevio.
La investigación examina cómo el alcoholismo afecta la salud, especialmente su vínculo con enfermedades hepáticas y cardiovasculares.
El alcoholismo debilita nuestro sistema inmune. Un reporte en esta edición analiza el impacto del alcoholismo en la salud, destacando su relación con enfermedades hepáticas y cardiovasculares.
Elmetotrexatoseutilizaampliamenteeneltratamiento de la artritis reumatoide. Sin embargo, puede desencadenar efectos hematológicos adversos como se relata en otro de nuestrosreportesdeestemes.
Esperamos que disfruten esta edición ¡Hasta el próximoencuentro!
“El progreso de la ciencia depende de la capacidad de cuestionarloqueseconsideraverdadero"(AlbertEinstein)
Dra. Paola Boarelli
Directora de Contenidos info@revistabioanalisis.com
Teléfono: (54 261) 681-6777 - Horario de Atención: de 9 a 17 hs.
Dirección General: Lic. Daniela Lamy I dlamy@revistabioanalisis.com
Directora de Marketing: Elda Bordin I mkt@revistabioanalisis.com
Directora de Contenidos: Dra. Paola Boarelli I contenidos@revistabioanalisis.com

Riesgo cardiovascular, dislipemias e indicación de estatinas en una población de obesos mórbidos
Pág. 8.
Pág 56. Mielosupresión inducida por metrotexato en artritis reumatoide

Síndrome de Ovario Poliquístico y la Resistencia a la Insulina
Pág. 22.
Formación de Posgrado. Pág 60
BioAgenda // Empresas. Pág 62 >>

Enfermedad de Von Willebrand adquirida en un Mieloma múltiple: reporte de caso
Pág 36.

Alcoholismo y respuesta inflamatoria: implicaciones en la enfermedad hepática y cardiovascula
Pág.46.



Este estudio revela la subestimación del riesgo cardiovascular en obesos mórbidos, destacando la necesidad urgente de un tratamiento adecuado para prevenircomplicacionesgraves.
1 1 Natasha Smiliansky , Franco Peverelli , Micaela
1 1 1 Tregarthen , So a Carozzi , Andrea Vaucher , Gustavo 1Bruno
1 Universidad de la República. Facultad de Medicina. Unidad de lípidos y Programa de Obesidad y Cirugía Bariátrica.HospitalMaciel.Montevideo,Uruguay. Correspondencia:nata.smiliansky@gmail.com
Fuente: Revista Uruguaya de Medicina Interna 2024; 9(1):e305.DOI:10.26445/09.01.8
RESUMEN
Introducción: La obesidad se relaciona con un riesgo cardiovascular (RCV) elevado. Esto nos obliga a tomar conductas terapéu cas y prevencionistas El obje vodeestetrabajoesevaluarelriesgocardiovascular enunapoblacióndeobesosmórbidosyvalorarlacorrecta indicacióndeesta nas.
Metodología: Estudio transversal, descrip vo,
observacional, con la población obesos mórbidos del Programa de Obesidad y Cirugía Bariátrica (POCB) del Hospital Maciel, desde noviembre del 2014 a marzo del 2020 El RCV se valoró con la calculadora de la organización panamericana de la salud. La indicación de esta nas se consideró según RCV o diagnós co de dislipemia.
Resultados:Seanalizaron478pacientes,el84.3% fueronmujeres,lamedianaparalaedadfuede44años,y parael IMC 50kg/m2.Secalculóun RCV bajo parael57% de los pacientes; y alto o muy alto para un 37%. La prevalenciadelasdislipemiasfue84,3%,apredominiode hipercolesterolemia (33,7%) y dislipemia aterogénica (19,5%) El 60 6% (290) de los pacientes presenta indicación de tratamiento con esta nas, solo el 38.9%. (113) las recibe. El 38.1% (43) alcanzan los obje vos terapéu cos.
Conclusiones: La obesidad presenta múl ples comorbilidades que aumentan el RCV, aun así, se encuentra subes mada por las calculadoras de riesgo. Quedaenevidenciauninfratratamientofarmacológicode






estos pacientes, no logrando los obje vos terapéu cos propuestos.
Palabras clave: Obesidad, cirugía bariátrica, dislipemia, riesgocardiovascular
>>>
La obesidad es una pandemia a nivel global, los úl mos datos de la OMS publicados en el 2016 informan que un 39% de la población mundial presenta sobrepeso (1) y un 13% obesidad. El estudio de Finkelstein et al pronos ca un aumento del 33% de la prevalencia de obesidad para el año 2030, determinando una alta morbimortalidad con altos costos para el sistema de (2,3) salud.
En Uruguay se es ma que una de cada cinco personas es obesa, según lo demuestra la Segunda Encuesta Nacional de Sobrepeso y Obesidad en Uruguay (ENSO 2) en el año 2006. Este estudio demuestra que un 34% de la población presenta sobrepeso (índice de masa 2 corporal (IMC) entre 25-29.9 kg/m ) y 20% obesidad 2 (4) (IMC >30kg/m ). Estosvaloressehanduplicadodesde elaño1980dondelaprevalenciadelaobesidaderadeun 13,3%,segúndatosdela OMS,hastalaactualidaddonde el 28.9% de los uruguayos mayores de 18 años es obeso. Esto posiciona a Uruguay en cuarto lugar según la prevalencia de obesidad entre los países de América (1) La na.
El riesgo cardiovascular (RCV) es ma la posible incidenciadedesarrollaruna enfermedadcardiovascular como infarto de miocardio, accidente cerebrovascular o muertecardiovascular(ECV)enunperiodode empode 10 años. El cálculo matemá co del RCV se desarrolló por primera vez en un estudio longitudinal llevado a cabo en la región de Framingham - Massachuse s; posteriormente fue estandarizado para Europa y diferentes (5) regionesdelmundo.
La importancia de calcular de manera individual en los pacientes el RCV es lo que permite una toma de (6) decisiones informada y basada en evidencia cien fica. Hoy en día contamos con múl ples calculadoras desarrolladas a par r de algoritmos que facilitan su u lización Es importante considerar que el RCV calculado difiere entre las dis ntas regiones geográficas debido a las diferentes prevalencias de los factores de riesgo para el desarrollo del proceso de aterosclerosis, entre ellos se incluyen factores gené cos, ambientales, (7) psicosociales y culturales. El cálculo del RCV según las guías de prác ca clínica internacionales se debería (8,9) realizarenpersonasapar rdelos40años.
La población de sujetos obesos presenta múl ples comorbilidades que aumentan el RCV, la
mayoría de las calculadoras de riesgo estandarizadas internacionalmente no incluyen el IMC como variable (10,11) para tener en cuenta a la hora de calcular el puntaje. La obesidad se relaciona con un RCV elevado, se evidenciaron alteraciones fisiológicas y metabólicas que lo explican, siendo el compromiso del metabolismo lipídicounodelosprincipalesfactoreseneldesarrollodel (12) procesodeaterosclerosis.
Las dislipemias se clasifican según las caracterís cas de las lipoproteínas en el perfil lipídico. Dentro de las principales alteraciones en esta población, se observa un incremento en la concentración colesterol LDL (cLDL), aumento de triglicéridos (TG), así como la presencia de par culas de cLDL pequeñas y densas asociado a la disminución de la concentración de colesterol HDL (cHDL), conocido como dislipemia (13,14) aterogénica(DA).
La DA está relacionada causalmente con el desarrollo y la progresión de la enfermedad cardiovascular, esto está demostrado en ensayos clínicos aleatorizados prospec vos con esta nas, donde se ha evidenciado que los pacientes con feno po de DA enen un mayor riesgo de episodios cardiovasculares que (15,16) aquellossinDA
Este aumento del riesgo se explica por el metabolismo de la lipoproteína ApoB, con aumento del númerodepar culasasociadasacLDLycVLDL,lacuales un indicador muy importante de aterogenicidad. Todas laslipoproteínasquecon enenApoBmidenmenosde70 nm de diámetro y pueden cruzar con mayor facilidad la barrera endotelial acumulándose en la matriz extracelular Este acúmulo de lipoproteínas es parte del complejo proceso fisiopatológico de acúmulo de lípidos en las paredes arteriales y la formación de un ateroma. (17,18)
En varios estudios de riesgo cardiovascular se demostró que el nivel de cLDL no reflejaba la carga real de todas estas lipoproteínas aterogénicas, por lo que se propone la determinación del colesterol no HDL (colesteroltotalmenoscHDL)comoobje voterapéu co paratodoslospacientesespecialmenteparaaquelloscon obesidad, hipertrigliceridemia, o diabetes, por lo que se considera un buen predictor de riesgo cardiovascular en (19,20) estosindividuos.
La DA es muy prevalente en esta población donde el RCV es superior al indicado por los niveles (21) plasmá cos de cLDL Las guías de prác ca clínica de Uruguaydel2019yla ESC 2021sugierenestrategiaspara considerar la intervención terapéu ca en función de la medición del RCV y las cifras de c-LDL en pacientes no (18) tratados. Otros factores para tener en cuenta que incrementan el RCV per se son la historia familiar de ECV prematura (hombres < 55 años, mujeres < 65 años),
síndrome metabólico, obesidad e insuficiencia renal crónica. Los pacientes con ECV establecida y niveles de cLDL mayores a 190 mg/dl son candidatos para iniciar tratamiento farmacológico, sin la necesidad de calcular RCV, al igual que los adultos mayores de 40 años con (22) diabetesmellitus po2.
Nuestro estudio plantea la hipótesis de que, en lospacientesobesos,el RCV yelriesgoaterogénicosegún el perfil lipídico se encuentra infravalorado, y por lo tanto existe un subtratamiento que hace a esta población vulnerable más expuesta las complicaciones de la enfermedadcardiovascular.
El obje vo del trabajo fue evaluar el riesgo cardiovascular en una población de obesos mórbidos y valorar la indicación de esta nas Los obje vos específicos fueron: describir el riesgo cardiovascular en una población de obesos mórbidos; describir los pos de dislipemias en una población de obesos mórbidos; determinar la indicación de esta nas en función del riesgo cardiovascular; analizar el cumplimiento de la indicación de esta nas en esta población; analizar el cumplimiento de los obje vos terapéu cos en los
pacientesbajotratamientoconesta nas.
1.Diseño del estudio: Se trata de un estudio transversal, descrip vo, observacional, con pacientes obesos mórbidos que concurren al Programa de Obesidad y Cirugía Bariátrica (POCB) del Hospital Maciel, en el periododesdenoviembredel2014amarzodel2021.
2 Población: Se evaluó una cohorte de pacientes pertenecientes al POCB del Hospital Maciel en la valoración preoperatoria por el médico internista al ingresar al programa. Los criterios de inclusión al POCB son pacientes mayores de 16 años con un IMC ≥ 35 kg/m2. Los pacientes candidatos a cirugía son valorados periódicamente previamente a la cirugía por un equipo mul disciplinario, complementando con estudios paraclínicos, asesoramiento en cuanto a nutrición, ac vidad sicaycambiodehábitos.
3 Criterios de inclusión: Todos los pacientes pertenecientes al POCB en ese período de empo, en valoración preoperatoria para cirugía bariátrica y que se

realizaronlosestudiosper nentes.
Criteriosdeexclusión:sincriteriosdeexclusión.
3.Definicióndevariables:Riesgocardiovascular
El RCV fue calculado u lizando la calculadora online de riesgo de la organización panamericana de la salud (OPS), herramienta validada para la población uruguaya (h ps:// www paho org/es/heartsamericas/calculadora-riesgo-cardiovascular).
Diagnós codedislipemias
La hipercolesterolemia se definió en función del RCV individual. Se consideró colesterol elevado a aquellos valores a par r de los cuales el tratamiento hipolipemiante está recomendado, que dependen del RCV calculado para cada persona de acuerdo a las Guías Nacionales de Dislipemia 2019. Para los pacientes con riesgo bajo o moderado se consideró un valor de cLDL mayor o igual a 130 mg/dl. Para los pacientes con riesgo alto, se tomó el valor de cLDL mayor o igual a 70 mg/dl. Para pacientes con riesgo muy alto se consideraron valores de cLDL mayores o iguales a 55 mg/dl Se contemplarontambiénaquellospacientesconvaloresen rango,perobajotratamientoprevioconhipolipemiantes.
La hipertrigliceridemia se definió según valores de triglicéridos (TG) superiores a 150 mg/dl, sin (8) alteracióndeotraslipoproteínas.
Se consideró hiperlipidemia combinada en los pacientes que presenten valores elevados de cLDL para su riesgo cardiovascular más triglicéridos mayores a 150 (8) mg/dl.
La hipoalfaproteinemia se definio como valores (8) de cHDL disminuidos según el sexo. El diagnós co de dislipemia aterogenica (DA) se definio como valores elevados de trigliceridos (mayores a 150 mg/dl) y cHDL disminuido según el sexo (hombres < 40 mg/dl y mujeres (8) <45 mg/ dl). En los pacientes que presentaban doble dislipemia (DA más otras dislipemias) se antepuso el diagnós codeDA
Indicacióndeesta nas
Se consideraron que los pacientes presentan indicación de esta nas según el riesgo cardiovascular y losobje vosdecLDLanteriormentedescritos.
Para la dislipemia aterogénica se consideró el colesterol no-HDL elevado (>145 para los pacientes con RCV bajo y moderado y>130para el RCV alto ymuy alto) según las recomendaciones de la sociedad española de (8) arteriosclerosis.
4.Recolección de datos: Se realizó el estudio del registro
dedatosdelospacientesdelPOCB,analizandolabasede datos del programa. Se obtuvieron las variables sexo, edad, peso, talla e IMC, antecedentes de tabaquismo, Diabetes Mellitus, HTA, cardiopa a, y tratamientos crónicos, así como los valores de, colesterol total, colesterol HDL, LDL y Trigliceridos Dichas variables fueron recolectadas en el contexto de la valoración preoperatoriodelospacientesdelprograma.
5.Procesamiento de datos: Los datos obtenidos fueron registradosenunabasededatos,dondefueronexcluidos datosfiliatorios.Lasvariablescuan ta vasseexpresaron comomedia±desvíoestándaromedianaeintercuar les según normalidad Las variables cualita vas se expresaron mediante porcentaje o números absolutos. Se u lizó el test de T o U Mann whitney para comparar variables cuan ta vas, y el test de chi² para las categóricas. Se consideraron significa vo un valor p< 0.05. Para el procesamiento de datos se empleó el paqueteestadís coSPSSversión26(Chicago,lllinois).
6 Aspectos bioé cos: Se u lizó la base de datos preexistente del POBC confeccionando una nueva planilla específica para este trabajo. Se registró la información de los pacientes sin datos filiatorios, manteniendo absoluta confidencialidad, y siendo el inves gador principal el único con acceso a esta informaciónsegúnlanorma valegalvigente:DecretoNº 158/019 y la declaración de derechos humanos de Helsinki. No se recibió financiación para la realización del estudio.
Se analizaron un total de 478 pacientes. El 84,5% (404) de la población estudiada fueron mujeres, con una mediana de edad de 44 años (RIC 15), 54% (258) hipertensos, 36,8% (176) diabé cos, 8,8% (42) con antecedentes de cardiopa a isquémica y 2,1% (10) con evento cerebrovascular previo. La mediana de IMC fue 2 2 50kg/m RIC11kg/m .Tabla1
Tabla1:Descripcióndelapoblación(n=478)
Variables continuas: mediana (RIC )
Edad (años) 44,0 (15)
Índice de masa corporal (kg/m2) 50 (11)
Variables categóricas: % ( población total )
Sexo
Masculino / Femenino
15,5 (74) / 84,5 (404)
Hipertensión arterial 54,0 (258)
Diabetes Mellitus
36.8 (176)
Enfermedad cardiovascular 10,9 (52)
Accidente cerebrovascular 2,1 (10)
Cardiopatía 8,8 (42)
Tabaquismo 12,8 (61)
Dislipemia
84,3 (403)
Sin dislipemia 15,7 (75)
Hipercolesterolemia 33,7 (161)
Hipertrigliceridemia 6,9 (33)
Dislipemia combinada 13,8 (66)
Dislipemia aterogénica
19,5 (93)
Hipoalfalipoproteinemia 10,5 (50)

Riesgo cardiovascular Bajo
57,9 (277)
Moderado 4,8 (23)
Alto 27,0 (129)
Muy alto 10,3 (49)
Las medianas de los valores de colesterol fueron: colesterol total (CT) 184 mg/dl (RIC 52 mg/dl), cLDL 111 mg/dl (RIC 41 mg/dl), cHDL 45 mg/dl (RIC 15 mg/dl), no HDL 138mg/dl(48)ytriglicéridos(TG)137mg/dl(RIC 79 mg/dl) El 23% (113) de los pacientes estaban en tratamiento con esta nas y el 5,9% (27) u lizaban otro hipolipemiante. Al definir los pacientes en función del riesgo cardiovascular, se evidenció que el 57,9 % (277) eran de bajo riesgo cardiovascular, 4,8% (23) de riesgo moderado, 27% (129) con riesgo alto y 10,3% (49) muy alto.Gráfico1.
Gráfico1:Riesgocardiovascular

En relación al diagnós co de dislipemias, 33,7% (161) de los pacientes presentaban hipercolesterolemia, 6,9% (33) hipertrigliceridemia y 13,8% (66) dislipemia combinada Se realizó diagnós co de dislipemia aterogénica a 19,5% (93) de los pacientes La hipoalfalipoproteinemia se evidenció en un 10,5% (50) de los pacientes. El 15,7% (75) de los pacientes no presentabadislipemia.Gráfico2
Gráfico2:Prevalenciadedislipemia

Según la indicación de tratamiento con esta nas se evidencio que el 60,6% (290) de los pacientes ene
indicación de recibirlas,pero de esos solo un 38,9%(113) las recibe. A su vez, de los pacientes que recibían esta nas, el 38 1% (43) alcanzan los obje vos terapéu cos Tabla 2. Se encontró un subtratamiento en función del riesgo cardiovascular en el 51,7% (247) pacientes.Gráfico3
Tabla2:Tratamientoconesta nas
Población total % (n=478)
Sin indicación ni tratamiento 39,4 (188)
Indicación de tratamiento 60,6 (290)
No recibe tratamiento 61,1 (177)
Recibe tratamiento 38,9 (113)
No logra objetivo terapéutico 61,9 (70)
Logra objetivo terapéutico 38,1 (43)
Gráfico3:Obje vosterapéu cos

Al estudiar los pacientes en función de sus comorbilidades, se evidencia que el 46,4% (70) de los diabé cos, 47,4% (93) de los hipertensos y el 57,1% (24) delosquepresentancardiopa arecibentratamientocon esta nas, logrando obje vos terapéu cos en 27,1% (19) 36,6% (34) y 20,8% (5) de los grupos respec vamente. Tabla3
Tabla 3: Indicación de tratamiento y obje vos según comorbilidades. Abreviaturas-DM: Diabetes Mellitus; HTA: Hipertensión arterial; n= número de pacientesconindicacióndeesta nas
No se encontraron diferencias significa vas en cuantoalcumplimientodeltratamientosegúnsexo.
La enfermedad cardiovascular es la primera causademuerteanivelmundial.Laes macióndelriesgo cardiovascular a 10 años es una estrategia relevante que
respaldaloscambiosdehábitosyconductasterapéu cas paraprevenireventosvasculares.Enlospacientesobesos este riesgo está definido principalmente por la presencia de comorbilidades, no estando contemplado en la herramienta de cálculo validada para América La na el peso o presencia de obesidad, infravalorando el riesgo (22,23) cardiovascular(RCV)enestapoblación.
En la población estudiada de pacientes obesos adultos, se evidencia que el 37% presenta un riesgo esperado de más de 10% para presentar un infarto de miocardio, un accidente cerebrovascular o un evento de muertecardiovasculara10años.Sedestacaqueel57,9% de los pacientes presentaban un RCV bajo (< 5%) lo cual se explica porque se trata de una población joven con un 39% de paciente menores de 40 años, los cuales no se encuentran contemplados en las calculadoras, siendo considerados de bajo riesgo, salvo que presenten comorbilidades como diabetes, enfermedad renal, (20) cardiovascularovaloresdecLDL mayoresa190mg/dl. Al evaluar los pacientes con riesgo bajo se observa que la mayoría(63,5%)sonmenoresde40años.
La relación entre la obesidad y la ECV fue
(24,25,26)
demostrada en varios estudios epidemiológicos, entre ellos un análisis de más de 300.000 adultos demostró la relación entre el IMC y la incidencia de (27) eventoscoronarios. Existenmúl plesmecanismosque explican la relación entre la obesidad y el RCV aumentado; entre ellos se describen la inflamación inducida por la obesidad que oxida las lipoproteínas de baja densidad, la resistencia a la insulina y el síndrome metabólico como procesos que aceleran la enfermedad (28,29) ateroscleró ca En un estudio en más de 7000 pacientes dislipémicos no obesos 4 de cada 10 sujetos presentaban RCV alto. (30) En cambio en una población de pacientes obesos en valoración preoperatoria para cirugía bariátrica estudiada por Largent et al, el RCV promedio fue de 10,6% (alto) según el score de (31) Framingham. En Argen na, Masson et al estra ficaron el riesgo cardiovascular en 474 pacientes con obesidad y sobrepeso (sin diabetes), u lizando diferentes calculadoras, evidenciando las diferencias entre ellas. Demostró que al usar el score de Framingham el 7,6% de los pacientes presentaban RCV alto, mientras que con la calculadora europea SCORE un 8,9% de los pacientes presentaban RCV alto y 1,6% muy alto, al calcular el riesgo según el nuevo puntaje de las guías



norteamericanasdela AHA 43%presentabanriesgobajo y 43% riesgo alto, estos úl mos resultados son comparables a los nuestros con el uso de la calculadora de OPS Esta distribución heterogénea del riesgo en una mismapoblacióndejaenevidencialaslimitacionesdelas (32) calculadoras tradicionales. Queda demostrada la relevancia de valorar el RCV complementando con el análisis de las comorbilidades en esta población, dada la importante prevalencia de pacientes de alto y muy alto riesgo, transmi endo al paciente el concepto de riesgo cardiovascularysusconnotacionesterapéu cas.
Varios estudios han demostrado la correlación entre el IMC y la prevalencia de dislipemias tanto en (33,34,35) poblaciones de obesos y no obesos. En nuestro estudio la prevalencia de las dislipemias es 84,3%, a predominio de hipercolesterolemia y dislipemia aterogénica, lo cual es superior a lo reportado por otros autores donde un 60-70% de los pacientes con obesidad (36,37,38) son dislipémicos. En los úl mos años ha surgido par cular interés en la dislipemia aterogénica (DA), esta secaracterizaporunaaltaconcentracióndepar culasde colesterol pequeñas y densas las cuales enen mayor poder aterogénico que el cLDL y por lo tanto determinan (39,40) un RCV aumentado. En un registro europeo de prevención secundaria EUROASPIRE III desarrollado en (41) 22 países, más de un tercio presentaban DA, en el estudioespañolDyslipidemiaInterna onalStudy(DYSIS) que incluyó 3.617 pacientes tratados con esta nas, la prevalencia de colesterol HDL bajo fue del 23,2%, la (42) hipertrigliceridemiafuedel36,8%,ylaDAdel13,1%. Si bienlaprevalenciadelaDAennuestroestudiofuesimilar a la reportada en la población general, son pocos los estudios específicos que evalúen la asociación de la DA y la obesidad. En otro trabajo español realizado en una población de 418,343 individuos se demostró la correlación entre la DA y el IMC (RPC 0.800 IC 0.797–0.803) donde el promedio de IMC en sujetos que (43) presentabanDAerasuperiora30kg/m2.
El tratamiento con esta nas disminuye el cLDL, por lo que reduce la morbilidad y la mortalidad de la enfermedad cardiovascular, también disminuye los triglicéridos y por lo tanto puede reducir el riesgo de pancrea s. La indicación de tratamiento con esta nas se valora de forma individualizada según el RCV y los obje vosdecLDLdeseadosparacadapaciente,peroesta no se encuentra estandarizada ya que las dis ntas guías deprác caclínicau lizandiferentespuntosdecortepara (15,18,21) eliniciodeltratamientofarmacológico.
El 60% de nuestros pacientes enen indicación de recibir tratamiento con esta nas, dentro de estos un 61% no lo recibe, si bien no se estudiaron las causas de este subtratamiento, estas pueden corresponder a una incorrecta autopercepción de la enfermedad por parte delpaciente,lanoadherenciaaltratamiento;oporparte
del profesional tratante por subes mación del RCV y la dislipemia. Estos datos son comparables con un estudio realizado por la Universidad de Stanford en más de 60.000 paciente con hipercolesterolemia severa (cLDL >190 mg/dl) sin ECV o diabetes, donde el 52% de los (44) pacientes se encuentra recibiendo esta nas. Estas cifras cambian en los estudios que valoran la prevención secundaria, donde el 80-95% de los pacientes recibe (45,46,47) esta nas. En cambio en nuestro trabajo este valor esde57%.
En cuanto a los obje vos terapéu cos la mayoría (52%)delospacientesennuestroestudionoalcanzanlos obje vos establecidos para su grupo de riesgo, dejando enevidenciaunimportanteinfratratamientoqueexpone a esta población a una mayor probabilidad de padecer eventos cardiovasculares. El estudio de Rodríguez-Roca desarrollado en pacientes en atención primaria, halló un buen control de la dislipemia en un 32% de los pacientes, donde además se demostró que el grado de control disminuye conforme aumenta el riesgo cardiovascular El mal control se asoció con la presencia de diabetes, nefropa a y tabaquismo y con antecedentes familiares de enfermedad cardiovascular prematura; el buen (30) control se asoció con el ejercicio sico Se destaca que en nuestro trabajo los pacientes diabé cos, hipertensos o con enfermedad cardiovascular cumplen mejor la indicación de tratamiento que los pacientes que no presentan comorbilidades A su vez una menor proporción son los que logran los obje vos terapéu cos teniendo en cuenta que estos son más estrictos. Estos datos nos demuestran la necesidad de asesorar y educar sobre hábitos saludables, así como considerar intensificar el tratamiento, op mizando las dosis de esta nas o asociando otros hipolipemiantes en los pacientesquenologranlosobje vosterapéu cos.
El riesgo cardiovascular y las dislipemias se encuentran infravalorados en los pacientes obesos, así comoeltratamientoconesta nas.
Esto pone en evidencia la necesidad de evaluar sistemá camente el RCV de estos pacientes, apoyándonos en herramientas de cálculo y en las guías estandarizadas para guiar y op mizar el tratamiento médico.
No existe ningún conflicto de interés que declarar
NOTADECONTRIBUCIÓNAUTORAL
Natasha Smiliansky: conceptualización, curación de
datos, redacción - borrador original, redacción –revisiónyedición.
Franco Peverelli: conceptualización, redacción –revisión y edición. Micaela Tregarthen: curación de datos, redacción – borrador original. So a Carozzi: curacióndedatos,redacción–borradororiginal.
Andrea Vaucher: conceptualización, redacción –revisiónyedición.
Gustavo Bruno: conceptualización, redacción –revisiónyedición.
Natasha Smiliansky: Especialista Medicina interna. AsistenteClínicaMédica.UnidadAcadémicaMédica 3.
Franco Peverelli: Especialista Medicina interna Diabetólogo. Profesor Adjunto Clínica Médica. UnidadAcadémicaMédica3.
Micaela Tregarthen: Residente Medicina interna. UnidadAcadémicaMédica3.
So a Carozzi: Residente Medicina interna. Unidad AcadémicaMédica3.
Andrea Vaucher: Especialista Medicina interna. Ex Profesor Adjunto Clínica Médica. Unidad Académica Médica3.
Gustavo Bruno: Especialista Medicina interna Profesor Agregado Clínica Médica. Unidad AcadémicaMédica3.
Los autores declaran que el conjunto de datosqueapoyalosresultadosdeesteestudionose encuentradisponibles.
El editor responsable por la publicación del presentear culoeslaDra.MercedesPerendones.

2030.AmJPrevMed[Internet].2012;42(6):563–70.
3-SwinburnBA SacksG,Hall KD,McPhersonK,FinegoodDT Moodie ML etal.Theglobalobesitypandemic:shapedbyglobal driversandlocalenvironments.Lancet[Internet].2011;378(9793):804–14.
4-Pisabarro DR Gu érrezM,BermúdezC.SegundaEncuestaNacionaldeSobrepesoyObesidad(ENSO 2)adultos(18-65años
omás).RevMedUrug[Internet].2009[cited2018May9];25:14–26.
5-Mahmood SS Levy D Vasan RS Wang TJ The Framingham Heart Study and the epidemiology of cardiovascular disease: a historicalperspec ve.Lancet.2014Mar15;383(9921):999-1008.doi:10.1016/S0140-6736(13)61752-3.
6-Campbell NRC Ordunez P Giraldo G, Rodriguez Morales YA Lombardi C, Khan T et al. WHO HEARTS: A Global Program to ReduceCardiovascularDiseaseBurden:ExperienceImplemen ngintheAmericasandOpportuni esinCanada.CanJCardiol. 2021May;37(5):744-755.doi:10.1016/j.cjca.2020.12.004.
7-Pavía-LópezAA Alcocer-GambaMA Ruiz-GastélumED,Mayorga-ButrónJL MehtaR,Díaz-AragónFA etal.Guíadeprác ca
clínica mexicana para el diagnós co y tratamiento de las dislipidemias y enfermedad cardiovascular ateroscleró ca. Arch CardiolMex.2022;92(Supl):1-62.English.doi:10.24875/ACM.M22000081.
8-Mostaza JM PintóX, Armario P, Masana L, Real JT, Valdivielso P, et al. Estándares SEA 2022 para el control global del Riesgo Cardiovascular ClinInves gArterioscler 2022May-Jun;34(3):130-179.doi:10.1016/j.arteri.2021.11.003.
9-Pearson GJ, Thanassoulis G, Anderson TJ, Barry AR Couture P Dayan N, et al. 2021 Canadian Cardiovascular Society Guidelines for the management of Dyslipidemia for the preven on of cardiovascular disease in adults. Can J Cardiol. 2021
Aug;37(8):1129-1150.doi:10.1016/j.cjca.2021.03.016.
10-Wilson PW D'Agos no RB, Levy D Belanger AM SilbershatzH, Kannel WB Predic on of coronary heart disease using risk factorcategories.Circula on.1998May12;97(18):1837-47.doi:10.1161/01.cir.97.18.1837.
11-ConroyRM,PyöräläK,FitzgeraldAP,SansS,Meno A,DeBackerG,etal.,SCOREprojectgroup.Es ma onoften-yearrisk of fatal cardiovascular disease in Europe: the SCORE project. Eur Heart J. 2003 Jun;24(11):987-1003. doi: 10.1016/s0195668x(03)00114-3.
12-Cunha CL A influência da obesidade e da a vidade sica no risco cardiovascular Arquivos Brasileiros de Cardiologia. 2022;119(2):244–5.doi:10.36660/abc.20220381
13-Climenta D, BenaigesaA, Godaya M, Villatoroa H, Juliàa JM Ramón JC, etal.Obesidad mórbida y dislipemia:impactode la cirugíabariátrica.ClinInves gArterioscler 2020;32(2):79-86.
14-Athyros VG Tziomalos K, Karagiannis A, Mikhailidis DP Dyslipidaemia of obesity metabolic syndrome and type 2 diabetes mellitus:thecaseforresidualriskreduc ona ersta ntreatment.OpenCardiovascMedJ.2011;5:24–34.
15-Arbelo A, Bruno G, Baldizzoni M. Guía Nacional para el abordaje de las dislipemias en el adulto Ministerio Salud Publica. Montevideo:MSP 2019.
16-Sniderman AD, Islam S, Yusuf S, McQueen MJ Discordance analysis of apolipoprotein B and non- high density lipoprotein cholesterolasmarkersofcardiovascularriskintheINTERHEARTstudy Atherosclerosis.2012;225:444–449.
17-Ference BA, Kastelein JJP, Ray KK, Ginsberg HN, Chapman MJ, Packard CJ, Laufs U, Oliver-Williams C, Wood AM, Bu erworthAS etal.Associa onoftriglyceride-loweringLPLvariantsandLDL-C-loweringLDLRvariantswithriskofcoronary heartdisease.JAMA2019;321(4):364-73.
18-Visseren F, Mach F, M. Smulders Y, Carballo D, C. Koskinas K, Bäck M, et al. Guía ESC 2021 sobre la prevención de la enfermedadcardiovascularenlaPrác caClínica.RevistaEspañoladeCardiología.2022;75(5).
19-ThanassoulisG,WilliamsK,YeK,BrookR,CoutureP Lawler PR deGraafJ Furberg CD,SnidermanA.Rela onsofchangein plasmalevelsofLDL-C,non-HDL-CandapoBwithriskreduc onfromsta ntherapy:ameta-analysisofrandomizedtrials.JAm HeartAssoc2014;3(2):e000759.
20-Ascaso JF, Millán J Hernández-Mijares A, Blasco M, Brea A, Díaz A, et al. Documento de consenso sobre el manejo de la dislipemiaaterogénicadelaSociedadEspañoladeArteriosclerosis.ClinInvestArterioscler 2017;29(2):86-91
21-Arne DK,Blumenthal RS,Albert MA,Buroker AB, Goldberger ZD,Hahn EJ, etal.2019 ACC/AHA guidelineontheprimary preven on of cardiovascular disease: A report of the American College of Cardiology/American Heart Associa on Task Force onClinicalPrac ceGuidelines.Circula on.2019;140(11).
22-Krämer V Corbalán R, Berríos X, Navarrete C, Tagle R, Acevedo M. ¿Sirven los marcadores de riesgo no tradicionales en la diferenciación del riesgo card ovascular en adultos jóvenes con exceso de peso? Rev sta médica de Chile 2013 Aug;141(8):1026–33.
23-Zubiaga L. Valoración del riesgo cardiovascular después de gastrectomía ver cal: compara va del IMC la adiposidad, el índicedeFraminghamyelíndiceaterogénicocomomarcadoresdeléxitodelacirugía.NutriciónHospitalaria2016;33.
24-Hubert HB, Feinleib M, McNamara PM, Castelli WP Obesity as an independentrisk factorfor cardiovascular disease: a 26yearfollow-upofpar cipantsintheFraminghamHeartStudy Circula on.1983;67:968–977.
25-Manson JE, Wille WC, Stampfer MJ, Colditz GA, Hunter DJ, Hankinson SE, Hennekens CH, Speizer FE. Body weight and mortalityamongwomen.NEnglJMed.1995;333:677–685.
26-FolsomAR StevensJ SchreinerPJ,McGovernPG Bodymassindex,waist/hipra o andcoronaryheartdiseaseincidencein
AfricanAmericans and Whites: Atherosclerosis Risk n Communi es Study Inves gators Am J Epidemiol 1998; 148:1187–1194.
27-Bogers RP Bemelmans WJ, Hoogenveen RT Boshuizen HC Woodward M, Knekt P et al. Associa on of overweight with increased risk of coronary heart disease partly independent of blood pressure and cholesterol levels: a meta-analysis of 21 cohortstudiesincludingmorethan300000persons.ArchInternMed.2007;167:1720–1728.
28-McGillHCJr McMahanCA HerderickEE ZieskeAW MalcomGT TracyRE StrongJP;forthePathobiologicalDeterminants of Atherosclerosis in Youth (PDAY) Research Group. Obesity accelerates the progression of coronary atherosclerosis in young men.Circula on.2002;105:2712–2718.
29-Powell-Wiley TM, Poirier P, Burke LE, Després J-P, Gordon-Larsen P, Lavie CJ, et al. Obesity and Cardiovascular disease: a Scien ficStatementfromtheAmericanHeartAssocia on.Circula on2021;143.
30-Rodríguez-Roca GC Llisterri JL, Barrios V, Alonso-Moreno FJ, Banegas JR, Lou S, et al. Grado de control de la dislipemia en los pacientes españoles asis dos en atención primaria. Estudio LIPICAP Clínica E Inves gación En Arteriosclerosis 2006; 18:226–38.
31-Largent JA, Vasey J, Bessonova L, Okerson T, Wong ND. Reduc- on in Framingham risk of cardiovascular disease in obese pa entsundergoinglaparoscopicadjustablegastricbanding.AdvTher 2013;30:684-696.
32-Masson W, Lobo M, Huerín M, Molinero G, Manente D, Pángaro M, et al. Estra ficación del Riesgo cardiovascular en pacientes con sobrepeso u obesidad en Prevención Primaria. implicaciones en la u lización de esta nas. Endocrinología y Nutrición.2015;62(2):83–90.
33-Zhu J, Zhang Y, Wu Y, Xiang Y, Tong X, Yu Y, et al. Obesity and Dyslipidemia in Chinese Adults: A Cross-Sec onal Study in Shanghai,China.Nutrients2022;14:232
34-Kuwabara M, Kuwabara R, Niwa K, Hisatome I, Smits G, Roncal-Jimenez C, et al. Different risk for hypertension, diabetes, dyslipidemia, and hyperuricemia according to level of body mass index in Japanese and American subjects. Nutrients. 2018;10(8):1011.
35-Ramón-ArbuésE,Mar nez-AbadíaB Gracia-TabuencaT Yuste-GranC,Pellicer-GarcíaB Juárez-VelaR,etal.Prevalenciade sobrepeso/obesidadysuasociacióncondiabetes,hipertensión,dislipemiaySíndromeMetabólico:EstudioTransversaldeuna MuestradeTrabajadoresenAragón,España.NutriciónHospitalaria.20197;36(1):51-59
36-Feingold KR. Obesity and Dyslipidemia. [Updated 2023 Jun 19]. In: Feingold KR, Anawalt B, Blackman MR et al., editors. E n d o tex t [ I nte r n et ] S o u t h D a r t m o u t h ( M A ) : M D Tex t co m I n c ; 2 0 0 0 - Av
: h ps://www.ncbi.nlm.nih.gov/books/NBK305895/
37-BaysHE,Toth PP,Kris-EthertonPM,AbateN,Aronne LJ,Brown WV,etal.Obesity,adiposity,anddyslipidemia:aconsensus statementfromtheNa onalLipidAssocia on.JClinLipidol.2013Jul-Aug;7(4):304-83.doi:10.1016/j.jacl.2013.04.001.
38-Lamon-Fava S, Wilson PW Schaefer EJ Impact of body mass index on coronary heart disease risk factors in men and women The Framingham Offspring Study. Arterioscler Thromb Vasc Bio 1996 Dec;16(12):1509-15 do : 10.1161/01.atv.16.12.1509.
39-BosomworthNJ Approachtoiden fyingandmanagingatherogenicdyslipidemia:ametabolicconsequenceofobesityand diabetes.CanFamPhysician.2013Nov;59(11):1169-80.
40-Lorenza AJ, Toth PP New Perspec ves on Atherogenic Dyslipidaemia and Cardiovascular Disease. European Cardiology 2020;15:1–9.
41-Kotseva K, Wood D de Backer G, de Bacquer D Pyrola K, Keil U et al. EUROASPIRE III: a survey on the lifestyle, risk factors and use of cardioprotec ve drug therapies in coronary pa ents from 22 European countries. Eur J Cardiovasc Prev Rehabil. 2009Apr;16(2):121-37.doi:10.1097/HJR.0b013e3283294b1d.
42-González-Juanatey JR Millán J Alegría E, Guijarro C, Lozano JV Vitale GC Prevalence and characteris cs of lipid abnormali es in pa ents treated with sta ns in primary and secondary preven on in Spain. DYSIS-Spain Study Rev Esp Cardiol.2011;64:286---94
43-Busquets-Cortés C, López C, Paublini H, Arroyo Bote S, López-González ÁA Ramírez-Manent J Rela onship between AtherogenicDyslipidaemiaandLipidTriadwithDifferentScalesofOverweightandObesityin418,343SpanishWorkers.JNutr Metab.2022Aug9;2022:9946255.doi:10.1155/2022/9946255.
44-Rodriguez F, Knowles JW, Maron DJ, Virani SS, Heidenreich PA Frequency of Sta n Use in Pa ents With Low-Density Lipoprotein Cholesterol ≥190 mg/dl from the Veterans Affairs Health System. Am J Cardiol. 2018 Sep 1;122(5):756-761. doi: 10.1016/j.amjcard.2018.05.008.
45-Galve E, Cordero A, Cequier A, Ruiz E, González-Juanatey JR. Grado de control lipídico en pacientes coronarios y medidas adoptadasporlosmédicos.EstudioREPAR RevEspCardiol.2016;69:931–8.
46-Burdiat G, Nosiglia H, Sandoya E, Burdiat D Olalde C, Tejada L. Prescripción de esta nas, adherencia y nivel de lípidos dos añosdespuésdeunahospitalizaciónporenfermedadcoronaria.RevUrugCardiol.2016;31:398-404
47-Rodriguez F, Knowles JW, Maron DJ, Virani SS, Heidenreich PA Frequency of Sta n Use in Pa ents With Low-Density
Lipoprotein Cholesterol ≥190 mg/dl from the Veterans Affairs Health System. Am J Cardiol. 2018 Sep 1;122(5):756-761. doi: 10.1016/j.amjcard.2018.05.008.


Este estudio revela la insulina libre como un biomarcador clave en el hirsutismo asociado al SOP, destacando la importancia de un manejo personalizado y multidisciplinario.
1 2
Diana Loami Salas Baltazar , Amy Jocelyn Mengual Ku , 3 DanielCanaanPerez
1HospitalGeneraldeZonaNo.20.México
2UniversidaddelasAmericasPuebla,México
3HospitalGeneraldeZonaNo.5,México
Correspondencia:idiansalas@gmail.com
Fuente: Ciencia La na Revista Cien fica Mul disciplinar 8(5),3332-3352.h ps://doi.org/10.37811/ cl_rcm.v8i5.13811
RESUMEN
Obje vo: Evaluar la asociación clínica y bioquímicaentreelsíndromedeovariopoliquís co(SOP) y la resistencia a la insulina, centrándose en los marcadores metabólicos y las manifestaciones clínicas, par cularmentelagravedaddelhirsu smo.
Material y Métodos: Se realizó un estudio
analí co, observacional, transversal, retrospec vo y unicéntrico en la Unidad de Medicina Familiar 57 de Puebla. El estudio incluyó a 169 mujeres diagnos cadas con SOP que acudieron al Ambulatorio de Ginecología y Obstetricia durante 2021. Se recogieron datos clínicos y bioquímicos en el momento del diagnós co y durante el seguimiento, incluidos nivelesde insulina, perfil lipídico y gravedad del hirsu smo según la escala de FerrimanGallwey. Se realizó un análisis de regresión lineal mul variado para evaluar la relación entre los marcadores de resistencia a la insulina y la gravedad del hirsu smo,ajustandofactoresdeconfusióncomolaedad yelíndicedemasacorporal(IMC).
Resultados: Si bien no se encontró asociación significa va entre los marcadores lipídicos (colesterol total, HDL, LDL) y la gravedad del hirsu smo, sí se observó una relación significa va entre los niveles de insulina libre y la gravedad del hirsu smo (p = 0,034). Después de ajustar por factores de confusión, la resistencia a la insulina, medida a través de los niveles de
insulina libre, siguió siendo el predictor más fuerte de la gravedaddelhirsu smo.El IMC mostróunatendenciano significa va (p = 0,08) hacia una posible asociación con el hirsu smo.
Conclusión: Los hallazgos sugieren que la resistencia a la insulina, par cularmente los niveles de insulina libre, es un factor crí co en la manifestación clínica del hirsu smo en pacientes con SOP. Abordar la resistencia a la insulina mediante intervenciones terapéu cas, como me ormina o modificaciones del es lo de vida, podría reducir la gravedad de los síntomas androgénicos y prevenir complicaciones metabólicas a largoplazoenestospacientes.
Palabras clave: síndrome de ovario poliquís co, resistencia a la insulina, hirsu smo, marcadores metabólicos,insulinalibre.
INTRODUCCIÓN
El síndrome de ovario poliquís co (SOP) es una de las patologías endocrinometabólicas más frecuentes en mujeres en edad reproduc va, con una prevalencia
es mada del 6% al 10% a nivel mundial. Este síndrome es una causa importante de infer lidad femenina, caracterizándose por anovulación crónica, hiperandrogenismo y la presencia de ovarios poliquís cos en ultrasonogra a. Además de las manifestaciones reproduc vas, el SOP ene implicaciones metabólicas significa vas, tales como resistenciaalainsulina,dislipidemiayunmayorriesgode desarrollar diabetes po 2 y enfermedades cardiovasculares.
AunquelafisiopatologíaexactadelSOPaúnnose comprende completamente, se cree que la resistencia a la insulina juega un papel central en la e ología de la enfermedad. Entre el 50% y el 70% de las mujeres con SOP presentan algún grado de resistencia a la insulina, incluso en ausencia de obesidad. Esta resistencia a la insulinanosolocontribuyealasalteracionesmetabólicas observadas en estas pacientes, sino que también exacerba los síntomas de hiperandrogenismo, como el hirsu smoyelacné,alaumentarlaproducciónováricade andrógenos.
La relación entre el SOP y la resistencia a la

insulina ha sido objeto de múl ples estudios. Se ha planteado que la hiperinsulinemia que acompaña a la resistencia a la insulina puede actuar como un potente es muladordelasecrecióndeandrógenosenlosovarios, lo que agrava los síntomas clínicos. Además, la hiperinsulinemia inhibe la síntesis hepá ca de la globulina transportadora de hormonas sexuales (SHBG), lo que aumenta los niveles de andrógenos libres en circulación, exacerbando aún más los signos clínicos del SOP
En los úl mos años, se ha reconocido que el SOP no es solo una patología reproduc va, sino un síndrome metabólico mul sistémico. Las pacientes con SOP enen un riesgo significa vamente mayor de desarrollar complicaciones metabólicas a largo plazo, incluyendo obesidad central, hipertensión arterial y síndrome metabólico.Laiden ficaciónprecozdeestosfactoresyla implementación de intervenciones adecuadas, como la modificacióndeles lodevidayelusodesensibilizadores de la insulina, son fundamentales para mejorar la calidad devidayprevenircomplicacionesmayores.
Diversos feno pos del SOP han sido descritos, y su severidad varía considerablemente entre pacientes. Este fenómeno sugiere que existen múl ples mecanismospatogénicossubyacentesqueaúndebenser comprendidos. Las diferencias en la expresión clínica y bioquímica entre pacientes sugieren que una combinación de factores gené cos, ambientales y hormonales está involucrada en el desarrollo del síndrome.
En este estudio, se pretende explorar la relación entre la resistencia a la insulina y la severidad del hirsu smo en mujeres con SOP El enfoque en los marcadores bioquímicos y clínicos, como la insulina libre y el perfil lipídico, busca arrojar luz sobre las posibles interacciones que influyen en las manifestaciones del síndrome, con el fin de mejorar el abordaje diagnós co y terapéu coenestaspacientes.
Revisiónbibliográfica
El síndrome de ovario poliquís co (SOP) es una delasafeccionesendocrinasmáscomunesenmujeresen edadreproduc va,conunaprevalenciaquevaríaentreel 6% y el 10% a nivel mundial, dependiendo de los criterios diagnós cos u lizados. A lo largo de los años, se han u lizado múl ples criterios diagnós cos para el SOP, siendo los más reconocidos los establecidos por el Consenso de Ro erdam en 2003, que incluyen anovulación crónica, hiperandrogenismo y ovarios poliquís cosdetectadosporultrasonogra a.
ResistenciaalaInsulinaySOP
Una de las caracterís cas metabólicas más
prominentes en el SOP es la resistencia a la insulina, que afecta entre el 50% y el 70% de las mujeres con esta condición, incluso en aquellas que no presentan obesidad. Estudios como los de Moghe et al. han demostradoquelaresistenciaalainsulinadesempeñaun papelcrucialenlafisiopatologíadelSOP,exacerbandolas alteraciones metabólicas y los síntomas androgénicos como el hirsu smo. La hiperinsulinemia que acompaña a la resistencia a la insulina ha sido iden ficada como un factor desencadenante en la producción excesiva de andrógenos por los ovarios, lo que agrava las manifestacionesclínicasdelSOP.
Además de sus efectos directos sobre la secreción de andrógenos, la insulina también reduce la producción de la globulina transportadora de hormonas sexuales(SHBG)enelhígado,aumentandoasílosniveles de andrógenos libres en circulación y exacerbando el hiperandrogenismo clínico. La asociación entre resistencia a la insulina y SOP ha sido un tema recurrente en estudios recientes, con inves gaciones enfocadas en las implicaciones metabólicas a largo plazo de esta condición,comoelriesgoelevadodedesarrollardiabetes po2,hipertensiónyenfermedadescardiovasculares.
MarcadoresBioquímicosenSOP
Los marcadores bioquímicos han sido una herramienta valiosa para entender la relación entre el SOP y la resistencia a la insulina. En par cular, estudios han explorado la relación entre los niveles de insulina libre y los síntomas androgénicos como el hirsu smo. Diversas inves gaciones han señalado que los niveles elevados de insulina libre son un indicador de resistencia alainsulinaypuedencorrelacionarseconlaseveridaddel hirsu smo en pacientes con SOP Sin embargo, otros marcadores como los niveles de colesterol total, HDL y LDL, no han mostrado una relación consistente con la manifestacióndelhirsu smo,loquesugierequenotodos los marcadores metabólicos están igualmente involucradosenlasmanifestacionesclínicasdelSOP.
TratamientosyManejodelSOP
El manejo del SOP ha evolucionado significa vamente en los úl mos años, con un enfoque creciente en la mejora de la sensibilidad a la insulina como estrategia terapéu ca clave. Los sensibilizadores de la insulina,comolame ormina,hanmostradoserefec vos en la reducción de la resistencia a la insulina, mejorando no solo los parámetros metabólicos sino también reduciendo la severidad del hirsu smo y otros síntomas androgénicos Además, se ha demostrado que las modificaciones en el es lo de vida, como la pérdida de peso y el aumento de la ac vidad sica, pueden ser eficacesparamejorarlasensibilidadalainsulinaymi gar losefectosdelSOP

A nivel farmacológico, el uso de sensibilizadores de la insulina como la me ormina ha mostrado resultadosprometedoresnosoloeneltratamientodelos síntomas del SOP, sino también en la prevención de complicaciones a largo plazo, como la diabetes y las enfermedadescardiovasculares.
En resumen, la literatura existente resalta el papel crucial de la resistencia a la insulina en la fisiopatología del SOP, así como la importancia de los marcadores bioquímicos en el diagnós co y tratamiento. A medida que la inves gación con núa avanzando, es fundamental profundizar en los mecanismos subyacentes que vinculan la resistencia a la insulina con las manifestaciones clínicas del SOP para op mizar su manejo.
Se diseñó un estudio analí co, observacional, transversal y retrospec vo, realizado en el Servicio de Consulta Externa de Ginecología del HGZ No. 20, IMSS Puebla, durante 2021-2022. La muestra incluyó mujeres de la tercera y cuarta décadas de la vida con diagnós co de SOP, que contaran con reportes de laboratorios completos. Se excluyeron pacientes a par r de la quinta década, sin reportes de laboratorio, con diagnós co previo de diabetes po 1 o sin seguimiento en consulta externa. Se midieron variables como género, edad, ocupación, comorbilidades, tabaquismo, colesterol total, HDL, LDL, glucemia, insulina libre y clasificación en la escala de Ferriman-Gallwey El muestreo fue no probabilís co por casos consecu vos, con un tamaño de muestra de 169 pacientes. Se realizó estadís ca descrip va y correlaciones de variables u lizando la prueba Chi-cuadrado, asumiendo un error alfa del 5%. El estudio fue financiado por el Ins tuto Mexicano del SeguroSocialylosinves gadores.
Limitacionesdelestudio
Este estudio presenta varias limitaciones que debensertenidasencuentaalinterpretarlosresultados.
Tamañodelamuestra:Sibienlamuestrau lizada (169pacientes)proporcionaunabasededatosadecuada para análisis preliminares, su tamaño rela vamente limitado puede restringir la capacidad de generalizar los hallazgos a poblaciones más amplias o diversas. Estudios con muestras más grandes podrían ofrecer resultados más robustos y aplicables en diferentes contextos clínicos.
Diseño retrospec vo: El diseño retrospec vo del estudio introduce ciertas limitaciones inherentes, principalmente relacionadas con la imposibilidad de establecer relaciones causales defini vas. Este po de
estudio depende de la calidad de los datos preexistentes, lo que podría generar sesgos en la recolección de información y limitaciones en la estandarización de las mediciones.
Falta de control sobre posibles factores de confusión: Aunque se realizó un análisis descrip vo y univariado, no se incluyó un análisis mul variable para controlar por factores de confusión como la edad, el índice de masa corporal (IMC), o la presencia de otras comorbilidades metabólicas (p ej , obesidad, hipertensión). Estas variables pueden influir en los resultados y, por tanto, es necesario tenerlas en cuenta enfuturosestudios.
Sesgodeselección:Altratarsedeunmuestreono probabilís co de casos consecu vos, existe la posibilidad de un sesgo de selección, ya que no se garan za que las pacientes incluidas sean representa vas de toda la poblaciónconSOPeinsulinorresistencia.
Falta de evaluación longitudinal: Este estudio no evaluó los cambios en los marcadores bioquímicos y clínicosalolargodel empo,loquelimitalacapacidadde evaluar cómo evolucionan los pacientes con SOP e insulinorresistencia a medida que se implementan diferentes intervenciones terapéu cas Un enfoque longitudinal sería valioso para observar el impacto de tratamientosalargoplazo.
A pesar de estas limitaciones, los resultados del estudio ofrecen valiosa información sobre la relación entre la insulina libre y la severidad del hirsu smo en pacientes con SOP. Sin embargo, los hallazgos deben interpretarse con precaución y validados con estudios futurosquesuperenestaslimitaciones.
Implicacionesparalaprác caclínica
Los hallazgos de este estudio enen varias implicaciones importantes para la prác ca clínica, especialmente en el manejo de mujeres con síndrome de ovariopoliquís co(SOP)yresistenciaalainsulina.
Evaluación temprana de la resistencia a la insulina: Dado que la insulina libre se correlacionó significa vamenteconlaseveridaddelhirsu smoeneste estudio, es crucial que los profesionales de la salud consideren la evaluación ru naria de la resistencia a la insulinaenpacientescon SOP,inclusoenaquellasque no presenten obesidad. Esto puede facilitar la iden ficación temprana de pacientes en riesgo de complicaciones metabólicas a largo plazo, como la diabetes po 2 y las enfermedadescardiovasculares.
Uso de sensibilizadores de insulina: Los resultados sugieren que la hiperinsulinemia y la
resistencia a la insulina pueden ser factores clave en la exacerbación del hirsu smo y otros síntomas clínicos de SOP Esto refuerza el papel de los sensibilizadores de insulina, como la me ormina, como tratamiento de primera línea para mejorar la sensibilidad a la insulina y mi gar los síntomas androgénicos, incluyendo el hirsu smo. La terapia con me ormina podría no solo mejorar el perfil metabólico, sino también reducir la gravedaddelhirsu smoenpacientesconSOP.
Abordaje personalizado del tratamiento: La correlación significa va entre los niveles de insulina libre y el hirsu smo sugiere que el manejo del SOP debe ser individualizado. Las pacientes con niveles elevados de insulina libre podrían beneficiarse más de tratamientos que mejoren la resistencia a la insulina, en comparación con aquellas cuyos perfiles bioquímicos no presenten alteracionesenlainsulina.Estodestacalaimportanciade un enfoque personalizado en el tratamiento del SOP, que se base en las caracterís cas metabólicas y clínicas de cadapaciente.
Intervenciones en el es lo de vida: Dado el papel central de la resistencia a la insulina en la fisiopatología del SOP, se deben priorizar las intervenciones que mejoren la sensibilidad a la insulina. Las modificaciones en el es lo de vida, como la mejora de la dieta, la pérdida de peso en pacientes con sobrepeso y la promoción de la ac vidad sica, deben ser consideradas como componentes esenciales en el manejo integral del SOP. Estas intervenciones no solo pueden reducir los niveles de insulina libre, sino que también pueden prevenir complicacionesalargoplazo.
Seguimiento y monitoreo con nuo: El estudio
refuerza la necesidad de un monitoreo con nuo de los biomarcadores metabólicos, como la insulina libre, en pacientes con SOP, para evaluar la eficacia de las intervenciones terapéu cas y ajustar los tratamientos según sea necesario. Un seguimiento regular también puede ayudar a detectar cualquier progresión hacia el desarrollo de condiciones asociadas, como diabetes o enfermedadcardiovascular.
En resumen, estos hallazgos subrayan la importancia de un enfoque mul disciplinarioque incluya el monitoreo temprano y con nuo de la insulina libre y la implementación de terapias dirigidas a mejorar la sensibilidad a la insulina para op mizar el manejo del SOP. Estas intervenciones no solo pueden mejorar los resultados clínicos en términos de hirsu smo, sino también reducir el riesgo de complicaciones metabólicas alargoplazoenestapoblaciónvulnerable.
ColesterolTotaleHirsu smo
Noseiden ficóunaasociaciónsignifica vaentre losnivelesdecolesteroltotalylaseveridaddelhirsu smo (p > 0.05). Esto sugiere que los niveles de colesterol total puedennoserunfactordeterminanteenlaexpresióndel hirsu smoenlapoblaciónestudiada.

ColesterolHDLeHirsu smo
Demanerasimilar,noseencontróunaasociación significa va entre los niveles de colesterol HDL y la severidad del hirsu smo (p > 0.05). Esto indica que el componente de lipoproteínas de alta densidad podría no tener una influencia directa en la manifestación del hirsu smo.
Ndecasosvalidos 169
2casillas(33.3%) hanesperadoun recuento menorque5 El recuento mínimo esperadoes.71.
ColesterolLDLeHirsu smo
Los resultados también revelaron la ausencia de unaasociaciónsignifica vaentrelosnivelesdecolesterol LDL y la severidad del hirsu smo (p > 0.05). Parece que el perfil lipídico general no está vinculado de manera relevante con la presentación del hirsu smo en la poblaciónestudiada.
Pruebas
GlucemiaCentraleHirsu smo
Noseevidencióunaasociaciónsignifica vaentre laglucemiacentralylaseveridaddelhirsu smo(p>0.05). Estosugierequelosnivelesdeglucosaenlaregióncentral del cuerpo pueden no desempeñar un papel destacado enlavariabilidaddelhirsu smoenestamuestra.
InsulinaLibreeHirsu smo
Seiden ficóunaasociaciónsignifica vaentrelos niveles de insulina libre y la severidad del hirsu smo (p = 0.034). Estos hallazgos sugieren que la resistencia a la insulina, indicada por los niveles de insulina libre, podría estar relacionada con la expresión del hirsu smo en la poblaciónestudiada.
CorrelacionesNoParamétricas
ElanálisisdecorrelacióndeSpearmanrevelóuna correlación significa va nega va entre los niveles de insulinalibreylaseveridaddelhirsu smo(rho=-0.199,p = 0.009). Esta relación sugiere una posible influencia inversaentrelainsulinalibreylagravedaddelhirsu smo.
ExpresióndeDatos
Se analizaron 169 expedientes de pacientes de 20 a 39 añosconSOP Losresultadosmostraronlosiguiente:
Colesterol Total e Hirsu smo: No se encontró una asociación significa va (p > 0.05) entre los niveles de colesteroltotalylaseveridaddelhirsu smo.
Colesterol HDL e Hirsu smo: Tampoco se iden ficó una asociación significa va (p > 0.05) entre los niveles de colesterolHDLylaseveridaddelhirsu smo.
Colesterol LDL e Hirsu smo: No se encontró asociación significa va(p>0.05)entrelosnivelesdecolesterolLDLy Hirsutismo






laseveridaddelhirsu smo.
Glucemia Central e Hirsu smo: No se evidenció una asociación significa va (p > 0.05) entre la glucemia centralylaseveridaddelhirsu smo.
Insulina Libre e Hirsu smo: Se iden ficó una asociación significa va(p=0.034)entrelosnivelesdeinsulinalibrey la severidad del hirsu smo. Un análisis de correlación de Spearman mostró una correlación significa va nega va (rho = -0.199,p = 0.009)entreinsulinalibreylaseveridad delhirsu smo.
AnálisisMul variable
Para proporcionar un análisis más robusto de la relación entre los marcadores bioquímicos y clínicos (insulina libre, colesterol, glucemia, etc.) y la severidad del hirsu smo, se realizó un análisis mul variable u lizando regresión lineal múl ple. Este método permite ajustar por posibles factores de confusión, tales como la edad, el índice de masa corporal (IMC), el tabaquismo, y lascomorbilidadespresentesenlaspacientes.
VariablesIncluidasenelModelo:
Variable dependiente: Severidad del hirsu smo (clasificacióndeFerriman-Gallwey).
Variablesindependientes:
o Insulinalibre
o Colesteroltotal
o ColesterolHDL
o ColesterolLDL
o Glucemiacentral
o Edad
o Índicedemasacorporal(IMC)
o Tabaquismo
o Presenciadecomorbilidades(HTA,Dm2)
ResultadosdelAnálisisMul variable
Insulina libre: Tras ajustar por las otras variables, los niveles de insulina libre con nuaron mostrando una asociación significa va con la severidad del hirsu smo (p < 0.05). Esto sugiere que, independientemente de otros factores como el IMC o la edad, la insulina libre sigue siendo un marcador clave en la manifestación de los síntomas androgénicos en pacientes con SOP Este resultadorefuerzalahipótesisdequelahiperinsulinemia es un factor determinante en la exacerbación del hirsu smo.
Colesterol Total, HDL y LDL: Ninguna de las variables relacionadas con los niveles de colesterol mostró una relación estadís camente significa va con la severidad del hirsu smo después de ajustar por los
factores de confusión. Esto sugiere que, aunque el SOP puede estar asociado con dislipidemia, los niveles de colesterol no son determinantes directos en la expresión clínicadelhirsu smoenestapoblación.
Glucemia Central: Al igual que con los lípidos, los niveles de glucosa central no mostraron una relación significa va con la severidad del hirsu smo. Estos resultados son consistentes con estudios previos que sugieren que la resistencia a la insulina, más que la glucemia, es el factor clave que impacta los síntomas androgénicosdelSOP.
Edad e IMC: Aunque la insulina libre fue la variable más relevante, el IMC mostró una tendencia no significa va (p = 0.08) a estar asociado con la severidad delhirsu smo,loquepodríasugerirquelaspacientescon mayor IMC enen una mayor predisposición a presentar síntomasmásseverosde SOP.Sinembargo,eltamañode la muestra podría haber limitado la detección de una relaciónmásrobusta.
Tabaquismo y Comorbilidades: No se iden ficó una asociación significa va entre el tabaquismo o la presenciadecomorbilidadesylaseveridaddelhirsu smo en este análisis. Esto sugiere que, al menos en esta muestra, estos factores no desempeñan un papel relevante en la variabilidad de los síntomas clínicos del SOP.
ImplicacionesdelAnálisisMul variable
El análisis mul variable confirmó que la insulina libresiguesiendoelfactormásfuertementeasociadocon la severidad del hirsu smo, incluso después de controlar por otros factores. Este hallazgo refuerza la necesidad de intervenir en la resistencia a la insulina como una estrategia clave para mi gar los síntomas androgénicos del SOP Aunque el IMC mostró una tendencia hacia la significancia, los resultados sugieren que las intervenciones dirigidas específicamente a mejorar la sensibilidad a la insulina podrían ser más efec vas en el manejo del hirsu smo que aquellas que se centran únicamenteenlareduccióndelpesoolamejoradelperfil lipídico.
Este análisis también subraya la importancia de un enfoque clínico personalizado, ya que el impacto de ciertos factores (como el IMC) podría variar entre pacientes, lo que sugiere que no todas las pacientes con SOP experimentarán los mismos beneficios con los mismostratamientos.
EnfoqueenlosAspectosClínicos
Los resultados de este estudio enen importantes implicaciones para la prác ca clínica, ya que
resaltan la relevancia de la resistencia a la insulina, medida a través de los niveles de insulina libre, como un factor clave en la manifestación del hirsu smo en pacientes con síndrome de ovario poliquís co (SOP). A con nuación, se detallan algunos de los aspectos clínicos más relevantes derivados de los hallazgos. Insulina Libre comoBiomarcadorClave.
Losniveleselevadosdeinsulinalibre,quereflejan una resistencia a la insulina significa va, se han correlacionado con una mayor severidad del hirsu smo en este estudio. Esto respalda la idea de que la insulina libre debe ser considerada un biomarcador clave en la evaluación de las pacientes con SOP Desde una perspec va clínica, este hallazgo sugiere que la medición de insulina libre debería formar parte del manejo estándar del SOP, par cularmente en aquellas pacientes que presenten síntomas androgénicos severos, como el hirsu smoyelacné.
Recomendación Clínica: La medición ru naria de insulina libre, junto con otras pruebas metabólicas como laglucosayelperfillipídico,podríaayudaraestra ficarel riesgodelaspacientesyguiareltratamiento.
TratamientosSensibilizadoresdeInsulina
Los resultados refuerzan el uso de sensibilizadores de insulina, como la me ormina, como una de las intervenciones terapéu cas más efec vas para pacientes con SOP, especialmente aquellas con resistencia a la insulina y manifestaciones severas de hirsu smo. La me ormina ha demostrado ser eficaz no solo en la mejora de la sensibilidad a la insulina, sino tambiénenlareduccióndelossíntomasandrogénicosyla normalizacióndelosciclosmenstruales.
Recomendación Clínica: Se sugiere considerar el uso de me ormina en pacientes con SOP que presenten resistencia a la insulina documentada y síntomas androgénicos severos, ya que podría mejorar tanto los parámetrosmetabólicoscomolossíntomasclínicos.
EnfoqueMul disciplinario
El SOP es una condición mul sistémica que afecta tanto los sistemas reproduc vos como los metabólicos. Como tal, el manejo debe involucrar a una variedad de profesionales de la salud, incluidos

ginecólogos,endocrinólogosynutricionistas.Unenfoque mul disciplinario permi ría un manejo más integral, abordando no solo los síntomas reproduc vos, sino también las complicaciones metabólicas a largo plazo, como el riesgo de desarrollar diabetes po 2 y enfermedadescardiovasculares.
Recomendación Clínica: Los equipos de salud deben incluir a endocrinólogos para abordar la resistencia a la insulina y prevenir el riesgo a largo plazo decomplicacionesmetabólicas.
IntervencionesenelEs lodeVida
Las modificaciones en el es lo de vida, incluyendo la pérdida de peso y el aumento de la ac vidad sica, han demostrado ser estrategias efec vas para mejorar la sensibilidad a la insulina y reducir la severidad de los síntomas clínicos del SOP. Este estudio refuerza la necesidad de implementar intervenciones tempranas en el es lo de vida para todas las pacientes conSOP,inclusoaquellasquenopresentanobesidad.
Recomendación Clínica: Se debe educar a las pacientes sobre la importancia de mantener un peso saludableyseguirunadietaequilibradaricaennutrientes que favorezcan la sensibilidad a la insulina, como la dieta mediterránea. La ac vidad sica regular también debe promoverse como parte de un plan integral de tratamiento.
SeguimientoyMonitoreoRegular
El SOP es una condición crónica, y los síntomas y complicaciones metabólicas pueden evolucionar con el empo. Por lo tanto, es fundamental que las pacientes reciban un seguimiento regular para ajustar el tratamiento según sea necesario En par cular, el monitoreo de los niveles de insulina libre y otros marcadoresmetabólicosescrucialparaevaluarlaeficacia delasintervencionesterapéu cas.
Recomendación Clínica: Las pacientes con SOP debensometerseaunseguimientometabólicoregular,al menos anualmente, para evaluar la resistencia a la insulina, los niveles de glucosa y lípidos, y ajustar el tratamientoenconsecuencia.
PrevencióndeComplicacionesaLargoPlazo
Las pacientes con SOP enen un mayor riesgo de desarrollar diabetes po 2, hipertensión arterial y enfermedades cardiovasculares. Los hallazgos de este estudio sugieren que la resistencia a la insulina desempeña un papel central en el desarrollo de estas complicaciones, lo que resalta la importancia de un manejo precoz y efec vo de la resistencia a la insulina
paraprevenirestasafeccionesalargoplazo.
Recomendación Clínica: El tratamiento del SOP no debe centrarse únicamente en la mejora de los síntomas reproduc vos, sino también en la prevención de complicaciones metabólicas a largo plazo La intervención temprana en pacientes con resistencia a la insulina podría reducir el riesgo de complicaciones futuras.
El síndrome de ovario poliquís co (SOP) es un trastorno complejo cuya fisiopatología sigue siendo objeto de intenso debate. Los resultados de este estudio refuerzan la idea de que la resistencia a la insulina desempeña un papel central en la manifestación clínica del SOP, par cularmente en la severidad del hirsu smo. Aunque no se encontraron asociaciones significa vas entre el colesterol total, HDL, LDL, y la severidad del hirsu smo, sí se iden ficó una correlación importante entre los niveles de insulina libre y la severidad de esta condición.
Estos hallazgos son consistentes con estudios previos que destacan la hiperinsulinemia como un motor clave en el aumento de la producción ovárica de andrógenos, lo que a su vez exacerba el hiperandrogenismo clínico manifestado en síntomas como el hirsu smo. Moghe et al. y otros han señalado que la insulina libre podría ser un biomarcador más preciso que otros indicadores metabólicos para evaluar la gravedad delasmanifestacionesclínicasdelSOP.Enestesen do,el presente estudio apoya la hipótesis de que la insulina libre está estrechamente vinculada con la severidad del hirsu smo, lo que refuerza la importancia de su monitorizaciónenelmanejodelSOP.
En este estudio, aunque no se encontraron asociaciones significa vas entre la severidad del hirsu smo y los niveles de colesterol total, LDL y HDL, los resultados sugieren que la insulina libre desempeña un papel crí co. Se observó una correlación nega va entre los niveles de insulina libre y la severidad del hirsu smo, lo que respalda la idea de que la hiperinsulinemia puede exacerbarlasmanifestacionesclínicasdelSOP
ComparaciónconEstudiosPrevios
Aunque varios estudios han evaluado la relación entre los niveles de colesterol y las manifestaciones clínicas del SOP, los resultados han sido mixtos. En este estudio, no se observó una asociación significa va entre los niveles de colesterol total, LDL y HDL con la severidad del hirsu smo. Esto está en línea con estudios que sugieren que, aunque las alteraciones lipídicas son comunes en el SOP, no siempre se correlacionan

directamenteconlossíntomasandrogénicos.Laausencia de una asociación significa va en estos marcadores lipídicos podría deberse a la heterogeneidad de los feno pos del SOP y a la variabilidad individual en la respuestametabólicaalaresistenciaalainsulina.
El hallazgo clave de este estudio es la correlación nega va entre los niveles de insulina libre y la severidad delhirsu smo.Estarelaciónsugierequelaspacientescon mayores niveles de insulina libre, que reflejan una mayor resistencia a la insulina, enden a presentar hirsu smo más severo. Este hallazgo concuerda con inves gaciones previas que han iden ficado la resistencia a la insulina comounfactorcentralenelaumentodelaproducciónde andrógenos en los ovarios, exacerbando así los síntomas clínicos.
ImplicacionesClínicas
Desde una perspec va clínica, estos resultados enenimportantesimplicacionesparaelmanejodelSOP
El hecho de que la insulina libre esté asociada con la severidad del hirsu smo refuerza la necesidad de un enfoque terapéu co que incluya la mejora de la sensibilidad a la insulina como un componente esencial en el tratamiento de las pacientes con SOP. Sensibilizadores de la insulina como la me ormina han mostrado resultados prometedores en la reducción de la severidad del hirsu smo y otros síntomas relacionados con el hiperandrogenismo. Por lo tanto, este estudio refuerzalaideadequeelmanejodel SOP debeenfocarse no solo en los aspectos reproduc vos, sino también en la resistenciaalainsulinaysusefectosmetabólicos.
LimitacionesdelEstudio
Es importante reconocer las limitaciones del presente estudio Como se discu ó previamente, el diseño retrospec vo introduce ciertas limitaciones en cuanto a la capacidad de establecer relaciones causales defini vas. Además, el tamaño de la muestra, aunque adecuado para análisis preliminares, podría no ser representa vo de todas las pacientes con SOP, y estudios con tamaños de muestra más grandes y diseños prospec vosseríanú lesparavalidarestoshallazgos.
FuturasInves gaciones
Dadoquelaresistenciaalainsulinapareceserun factor clave en la severidad de los síntomas androgénicos en el SOP, futuras inves gaciones deberían centrarse en estudios longitudinales que evalúen la evolución de los niveles de insulina libre y otros marcadores bioquímicos en respuesta a intervenciones terapéu cas. Además, sería valioso realizar análisis mul variables que incluyan otros factores clínicos y metabólicos, como el índice de masacorporal(IMC),laac vidad sicaylosantecedentes
familiares, para proporcionar una comprensión más integraldelainteracciónentreestosfactoresyelSOP
Este hallazgo es consistente con inves gaciones previas que destacan la resistencia a la insulina como un componente fundamental del SOP, contribuyendo no solo a los desórdenes metabólicos, sino también a los síntomas clínicos de hiperandrogenismo. Por tanto, el manejodelSOPdebecentrarseenmejorarlasensibilidad alainsulina,loquepodríami garalgunosdelossíntomas másproblemá cosdelsíndrome,comoelhirsu smo.
Estudios recientes han mostrado que el tratamiento con sensibilizadores de la insulina, como la me ormina, ha tenido resultados posi vos en la reducción del hirsu smo y otras caracterís cas androgénicas del SOP Sin embargo, es necesario seguir inves gando los mecanismos precisos que vinculan la resistencia a la insulina con el exceso de andrógenos en estaspacientes.
El SOP sigue siendo un desa o diagnós co y terapéu co, requiriendo múl ples estudios clínicos, bioquímicos y ultrasonográficos según los Criterios del Consenso de Ro erdam de 2003. Aunque los resultados de este estudio muestran que no todos los marcadores metabólicos enen una relación significa va con el hirsu smo, se encontró una asociación entre niveles elevados de insulina libre y mayor severidad del hirsu smo. Esto sugiere que la resistencia a la insulina podría estar relacionada con la expresión del hirsu smo enelSOP
En resumen, este estudio refuerza la importancia de la insulina libre como un biomarcador relevante para evaluar la severidad del hirsu smo en pacientes con SOP y destaca la necesidad de un enfoque clínico que priorice lamejoradelasensibilidadalainsulina.
El estudio indica que las pacientes con SOP y resistenciaalainsulina enenunaclaraasociaciónclínica con niveles elevados de insulina libre, lo que podría estar relacionado con la severidad del hirsu smo. Aunque otros marcadores metabólicos, como el colesterol y la glucosa, no mostraron una asociación significa va con el hirsu smo,lainsulinalibreemergecomounbiomarcador clave en la caracterización clínica del SOP Estos resultadossugierenqueestrategiasterapéu casdirigidas a reducir los niveles de insulina podrían ser eficaces en el manejo de las manifestaciones clínicas del SOP, en especialelhirsu smo.
Recomendaciones: Se recomienda realizar estudios adicionales para explorar los mecanismos específicosquevinculanlaresistenciaalainsulinaconlas
manifestaciones clínicas del SOP. Además, se sugiere la implementación de intervenciones tempranas dirigidas a mejorar la sensibilidad a la insulina, con el fin de minimizar las complicaciones a largo plazo en pacientes conSOP.
Bandeira-MarcheseanL,Brossardi-RamosR,Mara-SpritzerP MetabolicFeaturesofWomenwithPolycysi cOvarySyndromein La nAmerica.FrontEndocrinol2021;12:759835.doi:10.3389/fendo.2021.759835
Schneider D Gonzalez JR Yamamoto M, et al. The associa on of Policyrtuc Ovary Syndrome and Gesta onal Hypertensive
DisordersinaDiverseCommunity–BasedCohort.JPregnancy2019;2019:9847057.doi:10.1155/2019/9847057
Robinson SL, Ghassabian A, Sundaram R, et al. The associa ons of maternal polycys c ovary síndrome and hirsu sm with behavioralproblemsunoffspring.Fer lSteril2020;113:435-4.doi:10.1016/j.fertnstert.2019.09.034
Louwers YV Laven JSE Characteris cs of polycys c ovary síndrome throughout life. The Adv Reprod Health 2020;14: 2633494120911038.doi:10.1177/2633494120911038
Zawadski JK DunaifA. Diagnos ccriteriaforpolycys covary syndrome:towardsara onaleapproach.In:DuanifA, Givens JR
Hasel neF etal.(eds).Polycys cOvarySyndrome.Boston:Blackwell;1992:377-384.
JarretBY VantmanN,MerglerRJ,etal.Dysglycemia,NotAlteredSexSteroidHormones,AffectsCogni veFunc oninPolycys c OvarySyndrome.JournaloftheEndocrineSocietyOctober2019Vol.3,1858–1868.doi:10.1210/js.2019-00112
TeedeHJ,MissoML CostelloMF etal.Interna onalPCOSNetwork.Recommenda onsfromtheinterna onalevidence-based guidelinefortheassessmentandmanagementofpolycys covarysyndrome.Fer lSteril.2018;110(3):364–379.
Steegers-Theunissen RPM, Wiegel RE, Jansen PW, et al. Polycys c Ovary Syndrome: A Brain Disorder Characterized by Ea ng Problems Origina ng during Puberty and Adolescence. Interna onal Journal of Molecular Science 2020, 21, 8211;
doi:10.3390/ijms21218211
Ro erdam ESHRE/ASRM-Sponsored SOP Consensus Workshop Group.Revised 2003 consensus on diagnos c criteria and long-termhealthrisksrelatedtopolycys covarysyndrome.Fer lSteril2004;81.19-25.
Moghe P, Tosi F, Bonin C, et al. Divergences in Insulin Resistance Between the Different Phenotypes of the Polycys c Ovary Syndrome.JClinEndocrinolMetab2013;98:E628-37.DOI:10.1210/jc.2012-3908
FranksS.Controversyinclinicalendocrinology:diagnosisofpolycys covariansyndrome:indefenseoftheRo erdamcriteria.J Clin Endocrinol Metab 2006; 91:786-789. DOI: 10.1210/jc.2005-2501 Azziz R. Controversy in clinical endocrinology: diagnosis ofpolycys covariansyndrome:theRo erdam criteria are premature. JClin Endocrinol Metab 2006; 91:781-785. DOI: 10.1210/jc.2005-2153
Codner E, Villarroel C, Eyzaguirre FC et al. Polycys c ovarian morphologyin postmenarchal adolescents. Fer l Steril 2011; 95:702-6.e1-2.DOI:10.1016/j.fertnstert.2010.06.015
VillarroelC,MerinoPM LópezP etal.Polycys covarianmorphologyinadolescentswithregularmenstrualcyclesisassociated withelevatedan -Mullerianhormone.HumReprod2011;26:2861-2868.DOI:10.1093/humrep/der223
Carmina E, Oberfield SE, Lobo RA The diagnosis of polycys c ovary syndrome in adolescents. Am J Obstet Gynecol 2010; 203: 201.e1-5.DOI:10.1016/j.ajog.2010.03.008
RoeAH DokrasA.Thediagnosisofpolycys covarysyndromeinadolescents.RevObstetGynecol2011;4:45-51.
Rebar R, Judd HL Yen SS et al. Characteriza on of the inappropriate gonadotrophin secre on in polycys c ovary syndrome. J ClinEndocrinolMetab1976;57:1320-1329.doi:10.1172/JCI108400
Adashi EY Hsueh AJ,Yen SS Insulinenhancementofluteinizinghormoneandfollicle-s mula nghormonereleasebycultured pituitarycells.Endocrinology1981;108:1441-1449.DOI:10.1210/endo-108-4-1441
Sir-Petermann T, Muñoz A, Candia M, et al. LH secre on by the female pituitary: effect of testosterone and blockade of its receptor ExpClinEndocrinol1996;104(suppl.):20-22.
Sir-Petermann T Maliqueo M, Codner E, et al. Early metabolic derangements in daughters of women with polycys c ovary syndrome.JClinEndocrinolMetab2007;92:4637-42.DOI:10.1210/jc.2007-1036.


El artículo a continuación presenta un caso de Enfermedad de Von Willebrand adquirida secundaria a mieloma múltiple, destacando diagnóstico, tratamiento y la relaciónentreambascondicioneshematológicas.
AUTORES
1 1
Solange Brun , Florencia Bentancour , Maximiliano
1 2 2 1 Berro ,EloísaRiva ,CeciliaGuillermo ,IsmaelRodríguez
1 Universidad de la República. Facultad de Medicina. Unidad Académica de Medicina Transfusional y Hemoterapia.
2 Universidad de la República. Facultad de Medicina. UnidadAcadémicadeHematología. Correspondencia: entancourroballo@gmail.com; sbalistair671@gmail.com
Fuente: Revista Uruguaya de Medicina Interna. 2024; 9(1):e403.DOI:10.26445/09.01.11
La Enfermedad de Von Willebrand adquirida (EVW adquirida) es un trastorno hemorrágico adquirido poco frecuente, con caracterís cas clínicas y de
laboratorio similares a la Enfermedad de Von Willebrand congénita. Asociándose con enfermedades hematooncológicas, autoinmunes, cardiovasculares y tumores sólidos. Las gammapa as monoclonales cons tuyen un grupo heterogéneo de trastornos caracterizados por la proliferación de linfocitos B en los úl mos estadios madura vos o células plasmá cas que preservan la capacidad de producir una inmunoglobulina (Ig) monoclonal o alguno de sus componentes. Como consecuencia, se produce la aparición de una paraproteína o componente M (CM) en suero y/o orina que estará formado por la misma cadena pesada o ligera, y por regiones variables idén cas. Se presenta el caso de una mujer de 57 años, que se presenta con un síndrome hemorragíparo,alteracióndelacrasisensuvíaintrínseca, donde se diagnos ca EVW adq secundaria a Mieloma Múl ple (MM) con CM IgM 5,9 g/dl. El tratamiento tuvo como obje vos detener el sangrado, prevenir complicaciones y abordar precozmente la patología hemato-oncológicacausante.Parasuabordajerequirióla
realización de recambios plasmá cos terapéu cos (RPT) que tuvieron un rol de acción terapéu ca temprana y eficaz con excelente tolerancia. Ante el diagnós co se inició rápidamente poliquimioterapia siendo ésta una paciente candidata a trasplante de progenitores hematopoyé cos. El obje vo de la presentación de este caso clínico es destacar la importancia de un correcto y oportuno diagnós co ante la sospecha clínica de una coagulopa a secundaria a una enfermedad hematooncológica subyacente. Por lo que hacemos énfasis en el abordajemul disciplinario.
Palabras claves: enfermedad de Von Willebrand adquirida.Mielomamúl ple.
INTRODUCCIÓN
La enfermedad de Von Willebrand adquirido (EVW adquirida) es un trastorno hemorrágico poco frecuente adquirido, informado por primera vez en 1968, con caracterís cas clínicas y de laboratorio similares a la EnfermedaddeVonWillebrandhereditaria(1,2).
La EVW adquirida es causada por una deficiencia del factor de Von Willebrand (FVW) cuan ta va o cualita va. Los factores principales que dis nguen esta enfermedad incluyen la falta de trastornos hemorrágicos previos, el diagnós co a una edad avanzada, no contar con antecedentes familiares y la asociación con condicionessubyacentes.
El diagnós co debe sospecharse en adultos con sangrado mucocutáneo inusual asociado a trastornos linfoprolifera vos, mieloprolifera vos, autoinmunes y cardiovasculares (3). Los trastornos linfoprolifera vos y mieloprolifera vos representan alrededor del 50-60% de todosloscasosreportados(4).
El Mieloma múl ple (MM) es una neoplasia clonal de células plasmá cas en la médula ósea, caracterizada picamente por inmunoglobulinas séricas anormales en sangre periférica o parte de ésta. Es una neoplasiamalignatratable,peroincurable.
El MM eslaúnicadiscrasiadecélulasplasmá cas clonales que siempre está precedido por una fase premaligna, denominada gammapa a monoclonal de significadoincierto(MGUS),peronosiempredetectable. MGUS está presente en más del 3% de la población por encima de los 50 años y progresa a MM o enfermedad malignarelacionadaenunatasade1%poraño.Dadoque MGUS es asintomá co, más del 50% de los individuos al diagnós co con MGUS tenían esta condición durante más de 10 años antes del diagnós co clínico. La supervivencia del MM mejoró con la introducción de
fármacos inmunomoduladores e inhibidores del proteosoma en la década anterior, pero la tasa actual de supervivenciaa5añosnosuperael50%(5,6).
Se expondrá a con nuación un caso clínico que involucraestasenfermedades.
Paciente de sexo femenino, de 57 años, con antecedentes personales de gastri s diagnos cada por endoscopía diges va hace dos años en tratamiento con omeprazol. Ex tabaquista. Colecistectomizada. Anemia leve crónica tratada en alguna oportunidad con hierro. Sin antecedentes gineco-obstétricos relevantes, sin historiadesangradospatológicos.
Ingresó por un síndrome hemorragíparo dado por equimosis fáciles de reciente aparición y por sangrado prolongado de una semana de evolución posterior a exodoncia de pieza dental del maxilar inferior quenocedeconmedidaslocales.
Presentaba fa ga moderada sin otros elementos desíndromefuncionalanémico.
Del examen sico se destacaba palidez cutáneo mucosa, hematomas aislados de pequeño tamaño evolucionados en miembros superiores e inferiores. Sangrado ac vo a nivel gingival Sin repercusión hemodinámica.
De la paraclínica al debut destacaba una anemia crónica agudizada dado por una caída de 2 puntos del valor basal alcanzado un valor de hemoglobina de 6 g/dl, pura normocí ca y normocrómica, plaquetas 172.000/mm3, leucocitos 6,700/mm3. Crasis: TTPA 46 segundos, TP 95,7%, INR 1,02, Fibrinógeno 306. Debido al TTPA prolongado, se realizó Test de mezcla con plasma normal, donde se observó corrección del parámetro, correspondiendo a un déficit de los factores de la coagulación.
La paciente ingresó para valoración diagnós ca. La ac vidad coagulante del factor VIII (FVIII: C) fue de 23%,elan genodelfactorvonWillebrand(vWF:Ag)12% ylaac vidaddelcofactordeRistoce nafuede11%.
Se confirmó la coagulopa a, haciendo diagnós co de Enfermedad de Von Willebrand adquirida aunaenfermedaddesconocida.
En el funcional y enzimograma hepá co se observó hiperproteinemia, proteínas totales de 11g/dl. AntelasospechadeEVWadq.porunapatologíahemato-
oncológica,sesolicitóproteinogramaelectroforé coque evidenció hiperproteinemia total con una banda de aspectomonoclonalde5.90g/dLenlazonademigración de las beta 2 globulinas e hipogammaglobulinemia.
Inmunoglobulinas séricas con elevación de la concentracióndeIgM9870mg/dl,IgA32mg/dleIgG266 mg/dl. Cadenas livianas libres en suero Kappa 16,48 mg/L, lambda 4,75 mg/L, ra o Kappa/Lambda 3,47
Ionograma y función renal normal. Serologías virales nega vas.
SerealizóinterconsultaalequipodeHematología anteelplanteodequeestacoagulopa aseasecundaríaa unagammapa amonoclonal.
Dada la necesidad de realizar un procedimiento invasivosolicitadoparavaloracióndiagnos ca,Biopsiade médula ósea (BMO), en contexto de un pico monoclonal IgM elevado se realizaron dos recambios plasmá cos terapéu cos (RPT) con la extracción de una volemia plasmá caporprocedimiento.Seobtuvocomoresultado unadisminuciónenlaconcentracióndelpicomonoclonal (de 5.97 a 2.93 mg/dl) y aumento en el nivel de los
factores de la coagulación FVIII: C 54%, FVW: Ag 18%, FVW: CoR 21%. Debido al antecedente de sangrado gingival grave con requerimiento transfusional, se administró una dosis de 500UI/1200UI de FVIII/FVW como tratamiento profilác co inmediatamente previo a la biopsia junto con ácido tranexámico. No presentando complicaciones hemorrágicas durante ni luego del procedimiento.
De los estudios realizados se destacaba: Mielograma/BMO: infiltración de casi el 100% de células plasmá cas Los estudios de Inmuno pificación, Inmunofeno po e Inmunohistoquimica, confirmaron la clonalidad de las células y alejó diferenciales a otras neoplasiasdecélulasB.
Se confirmó el diagnós co de EVW adquirida Secundaria a Mieloma múl ple IgM Estadio de Durie SalmonIII-AISSI,IgMKappa(CM:5,9g/dl).
Para la estra ficación pronos ca se obtuvieron resultados con diferimiento en el empo de: LDH 213 U/L, beta 2 microglobulina 2,7 mg/L, albúmina 4,10 g/dl,

estudiocitogené cosinalteracionesy FISH noevaluable. Proteínas en orina de 24 horas (PU24) 0,04 g/L, 0,14 g/24hsnosignifica va.
TC de bajas dosis: múl ples lesiones lí cas en cráneo, cervicales, lumbo-sacra, pelvis no afectación de muroposterior,nicor cal.
De acuerdo con la clasificación de la IMWG se confirmó el diagnós co de un MM ac vo, la anemia de e ología mul factorial podría considerarse como un criterio CRAB, además de considerar los marcadores biológicos infiltración medular de más del 60%, ra o FLC 3.47.
Para recordar la estra ficación R-ISS aún usada enlaactualidad,correspondeaunestadioIestapaciente (supervivencia global –OS- a 5 años 82%, supervivencia libre de progresión –SLP- a 5 años 55%); véase como en este par cular es adecuado el uso de ISS (que prescinde del resultado citogené co) estadio I, (mediana de supervivencia62meses)
Se adjunta imagen ilustra va de un modelo vigente para comprender los mecanismos subyacentes a laEVWadquirida(tabla1y2).
Tabla1:Causasymecanismosfisiopatológicosde Enfermedad Von Willebrand adquirida Extraído de: Moro et al. Enfermedad de Von Willebrand adquirida en un linfoma linfoplasmocitario/ Macroglobulinemia de Waldenström:reportedecaso.(7)
Cardiovascular Estenosisaórtica,prolapsodeválvulamitral, endocarditis Adsorción–proteólisis
Farmacológico
Ciprofloxacina Ácidovalproico
Inmune LES,esclerodermia
Infecciones VirusEpsteinBarr VirushepatitisC ?
SíndromeslinfoproliferativosLeucemialinfoidecrónica
Tricoleucemia
GMSI
Waldenströn
LinfomanoHodgkin Mielomamúltiple
Leucemiamieloidecrónica
Síndromes mieloproliferativos
Trombocitemiaesencial Policitemiavera Mielofibrosisidiopática
Neoplasias Adenocarcinomagástrico TumordeWilms
Miscelánea Hipotiroidismo
Uremia
Proteólisis ?
Autoanticuerpos
Autoanticuerpos,proteolisis
Autoanticuerpos,adsorción
Autoanticuerpos
Autoanticuerpos,adsorción
Autoanticuerpos,adsorción
Autoanticuerpos,adsorción
Proteólisis
Adsorción,proteólisis ?
Adsorción,proteólisis
Adsorción,autoanticuerpos
Inhibiciónporácidohialurónico
Disminucióndesíntesis
Proteólisis
Tabla 2: Sensibilidad de las pruebas de laboratorio en Enfermedad Von Willebrand adquirida. Extraído de: Moro et al. Enfermedad de Von Willebrand
adquirida en un linfoma linfoplasmocitario/ MacroglobulinemiadeWaldenström:reportedecaso.(7)
La paciente fue valorada de forma mul disciplinaria guiado por Hemoterapia y Hematología. El tratamientoinicialmenteestuvodes nadoalacorrección de la coagulopa a, para detener el sangrado agudo y comenzar un tratamiento precoz de la patología de base. Recibió 1 unidad de sangre desplasma zada (SD) y plasma fresco congelado (PFC) 10 ml/kg, lo que op mizó elmanejodelaanemiaylacorrecciónparcialdelacrasis.
La paciente recibió RPT que se u lizó para disminuir los niveles elevados de la paraproteína IgM, evitar un síndrome de hiperviscosidad, y porque debía realizarse un procedimiento invasivo como la BMO El procedimientodeRPT serealizóconunseparadorcelular Spectra Op a ®, y fue una herramienta terapéu ca eficaz parareducirlaconcentracióndeestainmunoglobulinade distribución principalmente intravascular (en un 80%) (8,9,10).
Se realizaron dos recambios plasmá coterapéu cos,deunavolemiaporprocedimiento,comola paciente no presentaba sangrado ac vo hace varias semanasseu lizócomosolucióndereemplazoalbúmina al 4%, sin complicaciones hemorrágicas. Se obtuvo como resultado una disminución en la concentración del pico monoclonal y un aumento de los factores de la coagulación.
El perfil de la EVW adquirida corresponde a un po 1, nivel del FVW < 0.30 Ul/ml, relación CO:R/ Ag:FVW > 0,7. En pacientes some dos a cirugía menor o procedimientos invasivos menores, se considera aumentar los niveles de ac vidad del FVW > 0.50 UI/mL con desmopresina o concentrado de factor con la adición deácidotranexámico(11).
En este caso se u lizó concentrado de factor VIII/FVW, (Haemate P®, CSL BEHRING S.A.) dada la severidad de sangrado presentado, administrando una única dosis de 500 Ul/1200 UI de FVIII/FVW previo a la BMO. Haemate-P es un concentrado de FVIII/FVW, deshidratado, pasteurizado, estéril y liofilizado, derivado del plasma humano, que se u liza administrado por vía intravenosa en el tratamiento de pacientes con hemofilia
A o EVW Como agente coadyuvante se empleó ácido tranexámico,500mgvíaoralcada8horasdesdelas24hs previasalaBMOyc/8hspor5días.
En cuanto al tratamiento de la patología subyacente la paciente comenzó con un plan de poliquimioterapia en base a Ciclofosfamida 500 mg vía oral, Bortezomib 2,3 mg subcutáneo y Dexametasona 40 mgvíaoral.Serealizaronlassolicitudescorrespondientes al Fondo Nacional de Recursos para lograr op mizar el tratamiento de inducción con la adición de un inmunomoduladoreinhibidordeprotesoma.
LaEVWadquiridaaligualquelaformacongénita, cursa con un defecto cuan ta vo o cualita vo del FVW, una gran glicoproteína adhesiva que interviene en la hemostasia primaria y secundaria, actuando en la adhesión de las plaquetas al vaso sanguíneo, y es chaperonadelFVIIIdelacoagulaciónrespec vamente.
Existen tres grandes categorías de EVW según la deficiencia del FVW, po 1 el más frecuente (déficit
cuan ta vo parcial), po 2 (déficit cualita vo), y el po 3 (déficit cuan ta vo total). En el caso descrito, se trataría de una EVW adquirida de po 1. Según reportes internacionales el patrón más frecuentemente descrito es de una EVW adquirida de po 2. Se desconoce la verdadera prevalencia de la EVW adquirida, ya que muchos casos pueden ser silenciosos desde el punto de vistaclínicoypermanecersindiagnos car(3).
El diagnós co debe sospecharse en adultos con sangrado mucocutáneo inusual asociado a trastornos linfoprolifera vos, mieloprolifera vos, autoinmunes y cardiovasculares.
LosmecanismosdedisminucióndelFVWpueden ser de e ología inmune o no inmune, y muchas veces coexisten. En las enfermedades neoplásicas el mecanismo más probable propuesto es la presencia de Autoan cuerpos contra el FVW pero estos sólo se pueden confirmar en 20% de los casos debido a técnicas de baja sensibilidad y especificidad (12). Estos son mayormente de po IgG, raramente IgM, y excepcionalmente IgA Otra causa involucrada en linfomas es la adsorción del FvW por células malignas.

Mediante la expresión de moléculas de adhesión aberrantes en la superficie de las células tumorales se produce la unión del FvW a las mismas, lo que determina sudisminuciónenplasma(7).
En nuestro caso no se demostró un inhibidor y APTT con pool de plasma normal supone un mecanismo deadsorcióndelFVWporlascélulastumorales.
Dentro de las neoplasias malignas hematooncológicasconunpicoIgMinicialmente,porfrecuencia, las neoplasias linfoides fueron el primer planteo La Macroglobulinemia de Waldenström (MW)/ Linfoma linfoplasmocí co, Linfoma de la zona marginal. Más alejados estadios premalignos: gammapa a monoclonal designificadoincierto(MGUS)omielomalatente(SMM) perosealejabanporlapresenciadeanemiacrónicasiera consideradacomoelementodedañodeórganoblanco.
El estudio citomorfologico así como la ausencia de la mutación MYD88L265P apoyó el diagnós co del debut de MM IgM. Se remarca que la mutación MYD88L265P no es patognomónica de las discrasias plasmá cas ni de linfomas indolentes, se observa en el linfoma esplénico de la zona marginal (4%), amiloidosis IgM (71%), linfoma de tejido linfá co asociado a la mucosa (7%) y MW (67%- 90%).Sepuede concluirque la mutación MYD88 L265P está asociada específicamente con MW e IgM MGUS y su ausencia apoya al planteo de ésta excepcional en dad MM IgM. Es ú l para orientar a próximos estudios y encaminar una estrategia costoefec va.
Las pistas ú les para el diagnós co de MM incluyen la presencia de lesiones óseas lí cas (raras en MW)yunatranslocaciónent(11;14)(noocurreenMW). Los pacientes con MM IgM enden a tener una diferenciación plasmocí ca con alta expresión de CD138 e inmunoglobulina citoplásmica, mientras que MW expresaCd20.
La paciente no contaba con estudios inmunoproteicos previos, ni imagenológicos que hicieran plantear la evolución clonal de un estadio premaligno, destacando además que no todo MGUS progresa a MM, 1% por año puede progresar a MM (13). El Smoldering mieloma SMM (mieloma quiescente-latente) ocupa un lugar intermedio entre MGUS y MM sin signos de daños en órganos diana. El diagnós co precoz, su esta ficación oportuna de acuerdo con el riesgo de progresión y el seguimiento estrecho es la conducta actualmente aceptada, si bien hay una tendencia a realizar el tratamientoprecozyaenestosestadios(13).
El tratamiento de EVW adquirida se basa en el
tratamiento de la enfermedad de base, pero ante la urgencia como el Síndrome de Hiperviscosidad o ante maniobras invasivas el control de la coagulopa a es prioritario. Además, permite el inicio precoz del tratamiento, en este caso con poliquimioinmunoterapia enlainternación.
El MM es una enfermedad incurable y la supervivencia ha mejorado significa vamente en los úl mos 15 años gracias al desarrollado múl ples combinaciones de inmuno-poliquimioterapia y eventualmente el trasplante de progenitores hematopoyé cos (TPH), que logran la remisión de la enfermedad. Sin embargo, en su mayoría los pacientes recaen, y la duración de la remisión en el MM recidivante disminuye con cada régimen. Por tanto, actualmente su manejoescomounaenfermedadcrónica.
El conocimiento de las alteraciones gené cas y moleculares abre camino a nuevas terapias blanco “target” farmacológicos y de estra ficación para una medicina personalizada. Múl ples alteraciones que involucran la cadena pesada de la inmunoglobulina se han descrito como de mal pronós co. Se destaca la t (11:14) que además de ser ú l en la valoración diagnos ca está incluida en scores pronos co como mSMARTpropuestoporlaClínicaMayo.
El tratamiento del MM ha crecido exponencialmente en los úl mos años, reflejándose en la sobrevida de los pacientes, incluso fallecen por otras en dades y no por la progresión del MM. La respuesta es monitorizadaatravésdelosresultadosinmunoproteicos, con diferente grado de respuesta. La valoración y u lidad clínica por EMR (enfermedad mínima residual) aún no es deconsenso.
Diferentes son los esquemas de tratamiento Actualmente la clásica división de ser candidato o no a trasplante pauta la inducción, consolidación y mantenimiento En los países que cuentan con los recursos suficientes, se ha incorporado la droga Daratumumab al clásico triplete de inducción, cons tuido por un inmunomodulador (ej Lenalidomida), un inhibidor de proteosomas (ej Bortezomib) y dexametasona. Se destaca que existe a nivel internacional planes iniciales de cuatro drogas ejemplo adición de Carfilzomib en paciente de muy alto riesgo, entreotrasdrogas.
SibienelTPHesunaconductaaceptadadeforma precoz (ante 4 ciclos) en algunos casos es válido aplazarlo a 6 ciclos (considerando caracterís cas del paciente y de la agresividad de la enfermedad). Actualmente podemos generalizar que el gold estándar del régimen de


acondicionamientoparaunTPHexitosoenestapatología se rige por el aporte de Melfalan, MEL-140 o MEL 200 (mg/m2) de acuerdo a edad, comorbilidad y función renal. En nuestro país el TPH autólogo se realiza en un área de internación especializada, sabiendo que esta terapéu ca ende a tener su manejo en el ámbito ambulatorioanivelinternacional(14).
El mantenimiento con Lenalidomina o Botezomib, en nuestro país es sustentado por el Fondo Nacional de Recursos (FNR), Lenalidomida de administración oral para paciente de bajo riesgo como es esta paciente mejora la SLP y la OS Tiene un rol central paramantenerlarespuestaalcanzadatraselTPH,incluso recomendado para aquellos que no alcanzan una muy buena respuesta parcial –VGPR-. Sin embargo, debe sopesarse su dosificación y frecuencia, porque en múl ples oportunidades las citopenias como toxicidad limitan su administración, además de recordar el aumento de riesgo de cánceres secundarios asociados a la terapia. Aunque es claro el beneficio del mantenimiento faltan datos sobre la duración óp ma. Mútliples ensayos también están examinando si la duración del mantenimiento puede modificarse en funcióndelosresultadosdelaEMR,asícomoelbeneficio denuevasdrogas.
CONCLUSIONES
Se presentó el caso de una paciente sin historia previa de sangrados, que consultó por un síndrome hemorragíparoalaqueselediagnos cóunaEnfermedad de Von Willebrand adquirido secundario a un Mieloma múl ple IgM kappa en estadio avanzado Ambas patologías son de muy baja frecuencia, y el abordaje mul disciplinario permi ó su estudio integral y el inicio deunaterapiaadaptadaalriesgo.
CONFLICTODEINTERÉS
Losautoresdeclarannotenerningúnconflictode interés.
NOTADECONTRIBUCIÓNAUTORAL
Solange Brun: conceptualización, curación de datos, redacción – borrador original. Florencia Bentancour: conceptualización, curación de datos, redacción –borrador original Maximiliano Berro: redacción –borradororiginal,redacción–revisiónyedición.
Eloísa Riva: redacción – borrador original, redacción –revisiónyedición.CeciliaGuillermo:redacción–borrador original, redacción – revisión y edición. Ismael Rodríguez: redacción – borrador original, redacción – revisión y edición.
NOTADEREFERENCIAAUTORAL
Solange Brun: Residente de la Unidad Académica de MedicinaTransfusionalyHemoterapia.
Florencia Bentancour: Asistente de la Unidad Académica deMedicinaTransfusionalyHemoterapia.
Maximiliano Berro: Profesor Adjunto de la Unidad AcadémicadeMedicinaTransfusionalyHemoterapia.
Eloísa Riva: Profesora Agregada de la Unidad Académica deHematología.
Cecilia Guillermo: Profesora Directora de la Unidad AcadémicadeHematología.
Ismael Rodríguez: Profesor Director de la Unidad AcadémicadeMedicinaTransfusionalyHemoterapia.
El editor responsable por la publicación del presente ar culoeslaDra.MercedesPerendones.
1-Federici AB, Budde U, Castaman G, Rand JH, Tiede A Current diagnos c and therapeu c approaches to pa ents with acquired von Willebrand syndrome: a 2013 update. Semin Thromb Hemost. 2013 Mar;39(2):191201.doi:10.1055/s-0033-1334867.
2-Franchini M, Mannucci PM. Acquired von Willebrand syndrome: focused for hematologists. Haematologica.
2 0 2 0 A u g ; 1 0 5 ( 8 ) : 2 0 3 2 - 2 0 3 7 d o i : 10.3324/haematol.2020.255117.
3-TiedeA,RandJH,BuddeU,GanserA,FedericiAB.HowI treattheacquiredvonWillebrandsyndrome.Blood.2011 Jun 23;117(25):6777-85. doi: 10.1182/blood-2010-11297580.
4-Landgren O. Advances in MGUS diagnosis, risk stra fica on, and management: introducing myelomadefining genomic events. Hematology Am Soc Hematol Educ Program. 2021 Dec 10;2021(1):662-672. doi: 10.1182/hematology.2021000303.
5-van Nieuwenhuijzen N, Spaan I, Raymakers R, Peperzak V. From MGUS to Mul ple Myeloma, a Paradigm for Clonal Evolu on of Premalignant Cells. Cancer Res. 2018 May15;78(10):2449-2456.doi:10.1158/0008-5472.
6-Myeloma UK Myeloma and MGUS: A Guide for Gps [Internet] Edimburgo: Myeloma UK, [Acces:20/03/2024]
s e p t 2 0 2 1 . D i s p o n i b l e e n : h p s : / / w w w m y e l o m a o r g u k / w pcontent/uploads/2021/09/ Myeloma-UK-Myeloma-andMGUS-A-Guide-for-GPs.pdf
7-Moro I, Oliver C, Stevenazzi M, Guillermo C, Pierri S, Decaro J Enfermedadde Von Willebrand adquirida en un linfoma linfoplasmocitario/Macroglobulinemia de Waldenström. Rev. Méd. Urug. [Internet]. 31 de diciembre de 2010 [citado 27/05/2024];26(4):246-52.
D i s p o n i b l e e n : h p : / / w w w 2 r m u org.uy/ojsrmu311/index.php/rmu/ar cle/view/413
8-Mori H, Fukatsu M, Ohkawara H, Oka Y, Kataoka Y, Taito S, et al. Heterogeneity in the diagnosis of plasmablas c lymphoma, plasmablas c myeloma, and plasmablas c neoplasm: a scoping review Int J Hematol 2021 Dec;114(6):639-652.doi:10.1007/s12185-021-03211-w.
9-PadmanabhanA,Connelly-SmithL,AquiN,BalogunRA, Klingel R, Meyer E, et al Guidelines on the Use of Therapeu c Apheresis in Clinical Prac ce - EvidenceBased Approach from the Wri ng Commi ee of the American Society for Apheresis: The Eighth Special Issue.
J Clin Apher 2019 J
10.1002/jca.21705.
10-Szczepiorkowski ZM Indica ons for therapeu c apheresis in hematological disorders Semin H e m a t o l . 2 0 2 0 A p r ; 5 7 ( 2 ) : 5 7 - 6 4 . d o i : 10.1053/j.seminhematol.2020.07.008.
11-James PD, Connell NT, Ameer B, et al. ASH ISTH NHF WFH 2021 guidelines on the diagnosis of von Willebrand disease. Sangre Adv. 2021;5(1):280-300. doi:10.1182/bloodadvances.2020003265
12-EbyC.Pathogenesisandmanagementofbleedingand thrombosis inplasmacelldyscrasias.BrJHaematol.2009
2141.2008.07577.x.
13-Kumar S, Rajkumar VS. Is It an Ember or Is It a Flame? The Natural History of Smoldering Mul ple Myeloma. T h e H e m a t o l o g i s t
10.1182/hem.v20.2.202325
14-Rubia J de la, Mateos MV, Bladé J, Lahuerta JJ. San Miguel J, coord. Guía de Mieloma Múl ple [Internet]. Madrid: Grupo Español de Mieloma, [acceso 21/03/2024] 2021. Disponible en: h ps://www. sehh.es/images/stories/recursos/2021/06/15/GuiaMieloma-Mul ple-21-04-2021.pdf










Alcoholismo y respuesta inflamatoria: implicaciones en la enfermedad hepática y cardiovascular
En la siguiente investigación se analiza el impacto del alcoholismo en la salud, destacando su relación con enfermedades hepáticas y cardiovasculares, y la importanciadelaprevenciónyrespuestainflamatoria.
1
Chris an Gabriel Acosta Ricachih , Sheila Ive e 1 1 Quinapanta Serrano , Álvaro Paúl Moina Veloz 1UniversidadTécnicadeAmbato,Tungurahua,Ecuador Correspondencia:yuleydialcaide77@gmail.com
F u e n t e : R e v i s t a F i n l a y 2 0 2 4 1 4 ( 3 ) h ps://revfinlay.sld.cu/index.php/finlay/ar cle/view/14 27
El alcohol cons tuye una de las principales drogas consumidas en la historia de la humanidad. Entre las prioridades del sector de la salud en la actualidad se encuentra la prevención del consumo irresponsable del alcohol. Esta inves gación tuvo como obje vo analizar los factores inflamatorios que contribuyen al desarrollo de enfermedades hepá cas y cardiovasculares relacionadasconelalcoholismo.Serealizóunabúsqueda
de la literatura cien fica publicada entre los años 2019 y 2023 en las bases de datos PubMed, ScIELO, Scopus y Medline. El alcohol puede provocar daño en diversos tejidos y órganos. Entre los principales mecanismos que provocan estas lesiones se encuentran: las alteraciones enlarespuestainmune,elaumentoenelestrésoxida vo y las alteraciones de la me lación. Entre las múl ples afecciones que puede ocasionar se encuentran: la enfermedadcardiovascular,elictus,elcáncer,ladiabetes mellitus, el síndrome alcohólico-fetal, las alteraciones hepá cas y del sistema inmune. Se realizó una síntesis basada en la evidencia cien fica, que proporcionará a los profesionales de la medicina conocimiento actualizado sobre las consecuencias patológicas y fisiológicas que ocasionaelconsumodealcoholalargoplazo.
Palabras clave: alcoholismo; enfermedades cardiovasculares; enfermedades hepá cas alcohólicas; factoresderiesgo

El alcohol cons tuye una de las principales drogas consumidas en la historia de la humanidad, principalmente en Occidente. Es considerada como una droga portera, debido a que generalmente da paso al consumo del tabaco u otras sustancias ilegales. Su uso es nocivo a par r de que la persona sobrepasa los límites que se han determinado como normales para un (1) consumosinriesgo.
En este marco aparecen alteraciones conductuales como manifestación fundamental a corto plazo, además, afectaciones biológicas que aparecen producto de un consumo de forma habitual de esta sustancia. El alcoholismo es clasificado entre los cinco principales factores de riesgo de enfermedades crónicas no transmisibles, embrionarias, neurodegenera vas y (1) gastrointes nales,discapacidadymuerteenelmundo.
Su consumo ocasiona aproximadamente 2,5 millonesde muertes anuales, lo cual representa el4 % de la mortalidad en el mundo y se asocia con más de 60 enfermedades. Estudios a nivel mundial sugieren un aumento de su consumo per cápita en las próximas décadas, fundamentalmente en los países de América y (2) Asia.
Independientemente, del patrón de consumo, el alcohol puede producir más de 200 en dades y afecciones descritas en la décima revisión de la Interna onal Sta s cal Classifica on of Diseases and RelatedHealthProblemsdelaOrganizaciónMundialdela Salud(OMS)(ICD-10)(porsussiglaseninglés).Entreellas lasprincipalesson:
Enfermedad cardiovascular: la relación entre el consumo de alcohol y la enfermedad cardiovascular es compleja. Su consumo moderado se ha relacionado con una disminución en el riesgo de enfermedad coronaria.
Su consumo en exceso, en cambio, ocasiona varios efectos adversos que incluyen: insuficiencia cardiaca, (2) hipertensiónarterialyfibrilaciónauricular
Ictus: en pequeñas can dades, el alcohol ene un efecto protector con respecto al ictus isquémico, sin embargo, con dosis elevadas del consumo de alcohol el (2) riesgodeictushemorrágicoaumenta.
Diabetes mellitus: el desarrollo de esta enfermedad aumenta en la población con un consumo elevado de alcohol, en cambio, el riesgo disminuye en (3) bebedoresmoderados.
Cáncer: se cuenta con evidencia acumulada que relaciona de forma directa el consumo de alcohol con el desarrollo de múl ples cánceres como los de: mama,
boca, estómago, laringe, faringe, estómago y el (3) hepatocelular,entreotros.
Síndrome alcohólico-fetal: los efectos adversos del consumo de alcohol durante el embarazo incluyen retardo en el crecimiento intrauterino, afectaciones en el sistema nervioso central y afecciones faciales, además (3) delsíndromedeabs nenciaalnacimiento.
Sistema inmune: los patrones inadecuados de consumo de alcohol se relacionan con inmunosupresión, (3) comoseexplicarámásadelante.
Manifestaciones neurológicas: las afecciones máscomunesson:demenciayenfermedaddeWernicke(4) Korsakoff
Lesiones no intencionales: accidentes de tránsito, robos, agresiones, violaciones, suicidio y homicidios como consecuencia de la pérdida del control (4) delcomportamiento.
En el alcoholismo crónico se produce un estado pro-inflamatorio,unadesusmanifestacionesnotableses la hepatopa a alcohólica. Esta ac vación del sistema inmune se produce debido a que el consumo de alcohol es capaz de aumentar la permeabilidad de la barrera gastrointes nal, lo cual permite el paso del lipopolisacárido (LPS) bacteriano al torrente sanguíneo El etanol y el LPS provocan alteraciones en diversas células como las células denominadas natural killer, células dendrí cas, los macrófagos y los neutrófilos. Por otro lado, ocurre una ac vación de las células del sistema monocito/macrófago mediante de la ac vación de receptores de po toll (TLR) (por sus siglas en inglés), lo cual incrementa la secreción de citocinas proinflamatorias(IL-1,IL-6yTNF-αeIL-8)medianteelfactor nuclear-κB (NF-κB). Esta ac vación pro-inflamatoria mediadaporlosTLRestárelacionadademaneraín maal daño sular,aspectoquesedesarrollarámásadelante.La influenciadelalcoholenlascélulasdendrí casdetermina unincrementoenlasecreciónde IL-10yunadisminución delaIL-12,loquerepercuteenelnormalfuncionamiento (5) delsistemainmuneadapta vo.
La presente inves gación tuvo como obje vo: analizar los factores inflamatorios que contribuyen al desarrollodeenfermedadeshepá casycardiovasculares relacionadasconelalcoholismo.
Para esta revisión bibliográfica, se realizó una búsqueda exhaus va de la literatura cien fica publicada entre los años 2019 y 2023. Las bases de datos consultadas fueron: Scielo, Pubmed, Scopus y Medline. Se emplearon términos de búsqueda relevantes, como: alcoholismo, implicaciones para la enfermedad hepá ca, implicaciones para enfermedades cardiovasculares,
alcoholismo y su respuesta inflamatoria, causas patológicas de la enfermedad hepá ca y causas patológicas de la enfermedad cardiovascular. Se aplicaron filtros para limitar los resultados a los ar culos publicadosenelrangodefechasespecificado.
Fueron incluidas revisiones sistémicas, metaanálisis, ensayos clínicos, guías de prác ca clínica y revisionesbibliográficas.Seexcluyeronaquellosar culos que no fueron publicados en revistas con revisión por pares, que tuvieran una metodología explicada de forma insuficiente o no mostraran el texto en su totalidad. Fueronseleccionados21ar culos.
Una vez iden ficados los estudios relevantes, se extrajo la información per nente, que incluía el diseño delestudio,losmétodosqueseu lizaron,lapoblaciónde estudio, los hallazgos clave y las conclusiones Esta información se u lizó para elaborar una síntesis de la evidencia actual sobre el alcoholismo con su respuesta inflamatoria que conlleva a enfermedades hepá cas y cardiovasculares, además, se realizó una evaluación crí ca de la calidad de los estudios incluidos, mediante la u lización de herramientas de evaluación de la calidad
adecuadas para cada po de estudio. Esta evaluación permi ó iden ficar las fortalezas y debilidades de la evidencia existente y proporcionar recomendaciones para aplicar en la prác ca clínica basada en la mejor evidencia disponible. Finalmente, se realizó una síntesis de la información recopilada, con el obje vo de proporcionar a los profesionales de la medicina, conocimiento, basado en evidencia cien fica, sobre las consecuencias patológicas y fisiológicas que ocasiona el consumodealcoholalargoplazo.
Dañoorgánicoinducidoporconsumodealcohol
Elalcoholestotalmentecapazdeocasionardaño en diferentes tejidos y órganos. Existen mecanismos medianteloscualesseproduceestaafección,entreellos: alteraciones en la respuesta inmune, el aumento en el estrés oxida vo, alteraciones de la me lación, modificaciones postraduccionales de proteínas y la desregulación del metabolismo de los lípidos y vías de transducción de señales que terminan afectando la función y supervivencia celular. El hígado cons tuye el

órganodianaparalosefectosperjudicialesdeestadroga, pueselalcoholsemetabolizaporlascélulashepá cas,las cuales expresan niveles elevados de dos enzimas oxidantes:laalcohol-deshidrogenasaylacitocromoP450 2E1(CYP2E1)(porsussiglaseninglés),sinembargo,otros órganos: el intes no, el páncreas, el cerebro, los pulmones y el sistema inmunitario, también, pueden verse afectados por el alcoholismo, además, el alcohol puede ser un factor que conlleve a la progresión del cáncer, las enfermedades autoinmunes y las infecciones (6) virales.
Patogeniadelaenfermedadhepá caalcohólica
La enfermedad hepá ca alcohólica (EHA) está comprendida en un gran espectro de en dades con daño hepá co; las cuales van desde una esteatosis hasta la cirrosis hepá ca, también es común encontrar en estos pacientes otras comorbilidades que afectan al hígado de forma prioritaria, entre ellas la esteatohepa s no (7) alcohólicaylashepa svirales.
El consumo de alcohol se relaciona ín mamente con la aparición de EHA y cirrosis hepá ca, no obstante, se hace di cil establecer una dosis fija de consumo de alcohol o límite a par r del cual, el consumo de alcohol provoca enfermedad hepá ca. Existen muchos factores queinfluyeneneldesarrollode EHA:edad,sexo,colorde la piel, patrón de consumo. Un metaanálisis en el que se revisaron 17 diferentes estudios, arribó a indicios de los límites necesarios en el consumo de alcohol que podría poner en marcha el mecanismo de lesión hepatocelular, sin embargo, pudo llegar a la conclusión de que existe un mayorimpactodelconsumodealcoholenlamortalidady la morbilidad, así como un riesgo elevado a desarrollar cirrosis hepá ca, que fue mayor en mujeres que en hombres, ambos llevaban una ingesta de alcohol de (7) manerasimilar.
La EHA se clasifica por lo general en función de sus diferentes fases de evolución: esteatosis hepá ca, esteatohepa s alcohólica, fibrosis, cirrosis hepá ca y carcinoma hepatocelular. La esteatosis hepá ca se desarrolla en alrededor del 90 % de los pacientes con un consumodealcoholsuperioralos60gramosdealcoholal día. Esta afección, generalmente, cursa de forma asintomá ca y puede ser reversible con la abstención del consumo de alcohol durante un empo corto El desarrolloyevoluciónalaesteatohepa salcohólicaaún noestátotalmenteexplicado.Algunasseriesseñalanque un porcentaje reducido de pacientes con esteatosis desarrollarán esteatohepa s y que entre un 10 y un 20 %deestospadeceráncirrosishepá ca.Laevolucióndela EHA en sus etapas avanzadas no está definida por completo, existen una serie de factores gené cos y no gené cos, donde la con nuidad del consumo de alcohol (8) esdeterminante.
Efectotóxicodirectodeletanol
En la ingesta de una bebida alcohólica, el alcohol contenidoseabsorbeenelestómagoeintes nodelgado. Si bien una pequeña porción es absorbida a través de la mucosa del primero, la mayor parte pasa al torrente sanguíneo por las paredes del segundo. Por su bajo peso molecular, no requiere diges ón y se absorbe de forma directa, por lo que llega a su concentración máxima en sangreentrelos30y90minutosdespuésdesuinges ón. Sumetabolismo enelugar,principalmente,enelhígado, se eliminan alrededor de un 10 % del alcohol ingerido sin transformación por medio del aire expirado, la orina y el sudor. Existen diversos factores que influyen en la absorción y el metabolismo del alcohol (sexo, edad, color de la piel, peso corporal, etc.). La principal vía metabólica consiste en la oxidación del etanol en acetaldehído en el citosol del hepatocito. Este proceso se realiza por la ac vidad de la enzima alcohol-deshidrogenasa (ADH), que u liza como cofactor a la nico namida adenina dinucleó do (NAD). La ADH se encuentra en su mayor parte en el tracto gastrointes nal y el hígado. Existen otras dos vías encargadas de la oxidación del etanol: las catalasas,cuyosnivelesenelhígadosonmuypequeñosy la oxidación mediante el sistema oxida vo microsomal delre culoendoplásmicobasadaenelcitocromoP450y, en específico la CYP2E1. En condiciones normales ambas aportan solo el 10 % de este proceso, sin embargo, la CYP2E1 en específico, es inducible por sustrato, por lo que su ac vidad crece de forma exponencial con el consumo crónico de alcohol. La CYP2E1 se expresa en mayorproporciónenlazonaperivenosadelhepatocitolo que explica el mo vo por el cual la lesión hepá ca inducida por el alcohol es más común en la zona (7) centrilobular.
El acetaldehído cons tuye el producto final de estas vías de metabolización. Este se transforma en acetato mediante el aldehído deshidrogenasa (ALDH) localizada en las mitocondrias y el citoplasma de las (8) células hepá cas por lo general. Esta reacción está catalizadaporelsistemaNAD+/NADH,loqueprovocaun desequilibrio que resulta en la acumulación de NADH, la generación de radicales libres de oxígeno (RLO) y el consumo de oxígeno necesario para realizar este proceso. El efecto tóxico directo ocasionado por el acetaldehído es uno de los responsables de la alteración en la permeabilidad gastrointes nal producida por el etanol, esto conlleva al incremento de la concentración de endotoxina bacteriana lipopolisacárido (LPS) de la paredcelulardelasbacteriasgramnega vasquellegaala circulación portal. Este incremento de concentración en los niveles plasmá cos de lipopolisacárido, ac va mediante el receptor 4 de po Toll-like (TLR4) (por sus siglas en inglés), a las células del sistema monocitomacrófago (que incluye a los monocitos de sangre

periférica,alascélulasdeKüpfferhepá casyalaastroglía cerebral), por tanto, induce la secreción de citoquinas (9) proinflamatorias.
Finalmente, puesto que todo este complejo enzimá co mencionado con anterioridad (ADH, ALDH y CYP2E1) está en el hígado, la mayor parte del efecto tóxicodirectodelaingestadealcoholafectaasuscélulas. (10)
Alteración del metabolismo celular e inducción del estrés oxida vo
Tal como se explicó, el metabolismo del etanol provoca una alteración del equilibrio NAD+/NADH, con laconsiguienteacumulacióndeNADH,también,conlleva a un aumento del consumo de oxígeno; se altera el metabolismo energé co celular y la capacidad de producir adenosina trifosfato (ATP) (por sus siglas en inglés), así como el aumento en las concentraciones de los RLO y de especies de oxígeno reac vo (EOR), o Reac ve Oxygen Species (ROS) (por sus siglas en inglés). Estos radicales se unen al etanol o a átomos de hierro y forman metabolitos como radicales hidroxilos (OH) u óxido ferroso (FeO), los cuales son responsables de la peroxidación liposomal de las membranas celulares. Las mitocondrias,elre culoendosplasmá co,pormediodel CYP2E1 y las células de Küpffer (gracias a la NADPH oxidasa), son las principales fuentes de ROS. El hierro se implica en el estrés oxida vo y promueve la fibrosis mediante la catálisis de la formación de ROS; todo esto ocurre durante la lesión hepá ca producida por el (11) alcohol.
De igual manera existen mecanismos que protegen frente al estrés oxida vo. Uno de los más estudiados es la hemoxigenasa-1 (OH-1), la cual bloquea la ac vidad de la CYP2E1 y reduce la generación de ROS. El efecto citotóxico del metabolismo del alcohol provoca la muerte celular mediante apoptosis y necrosis. Hay evidenciadelapresenciadepatronesmolecularesquese asocian al daño, Damage-Associated Molecular Pa ern (DAMP) (por sus siglas en inglés), que se liberan tras la muerte celular, provocan la ac vación de macrófagos y neutrófilos, la regeneración hepá ca y la fibrogénesis. Al final, el factor 3, regulador del interferón (IRF-3) (por sus siglas en inglés), conecta el estrés oxida vo con la mitocondria y provoca la apoptosis del hepatocito por la ac vación de las caspasas, también, ocasiona inflamación hepá ca mediante las células mononucleadas es muladas por las vías del interferón y (12) elNF-κB.
Alteracióndelsistemainmuneinnato
Es importante destacar en la respuesta inmune
innata el papel que juegan los neutrófilos, cells natural killer (NK) (por sus siglas en inglés) y células dendrí cas. Losneutrófilossonreclutadosconrapidezenlaszonasde infección o lesión. Al estar ac vados, pueden fagocitar patógenos,secretandiferentescitoquinasinflamatoriasy forman las llamadas trampas extracelulares de neutrófilos,NeutrophilExtracellularTraps(NETs)(porsus (12) siglaseninglés).
La función principal de las células dendrí cas es la de presentar an genos a las células T de los ganglios linfá cos, también, forman parte de la inmunidad innata donde fagocitan patógenos e intervienen en la produccióndeinterferón poIenrespuestaainfecciones virales El consumo crónico de alcohol origina una disminución en las células dendrí cas circulantes y alteraciones en su diferenciación. En cambio, otros estudios realizados no muestran una disminución en la producción de las citoquinas proinflamatorias con respecto a los controles, mientras que otros incluso (12) encuentranunaumentodeestas.
Lascélulas NK cumplenunpapelfundamentalen el reconocimiento y eliminación de células infectadas o alteradas. La inges ón frecuente de alcohol, ocasiona un descenso en la producción de granzimas y perforinas, de sucitotoxicidadydelainmuno-vigilanciafrentealcáncer. (13)
Hepatopa aalcohólica,disbiosisysistemainmune
Tal como se ha comentado con anterioridad, el componente esencial de la EHA es la inflamación. La translocación bacteriana juega un papel importante en este úl mo punto, debido a que el alcohol parece provocar una alteración de la barrera intes nal que, combinada con un aumento de la permeabilidad microvascular, ocasionan un aumento de los niveles sanguíneos de LPS y ADN bacteriano. El LPS es una endotoxina que, al unirse a los TLR4, puede provocar inflamación debido a la ac vación del sistema de citoquinas proinflamatorias a través de la vía del factor nuclear potenciador de las cadenas ligeras kappa de las células B ac vadas (NF-κB); lo que demuestra que la gravedaddelalesiónhepá casecorrelacionademanera lineal con su concentración en sangre. Tras la unión del LPS a los receptores TLR4, se produce la ac vación de las célulasdeKüpffer,enlacualestánimplicadastantoelNFκB como proteínas quinasas ac vadas por mitógenos. Al estar ac vadas, las células de Küpffer secretan ROS, quimioquinas IL-8 y CCL2, también, conocidas como citoquinasquimiotác cas.Sonproteínasdepocotamaño ybajopesomolecular(de8a14kDa)quepertenecenala familia de las citoquinas. Se nombran así debido a que al inicioseiden ficaronporsucapacidaddeac var,atraery dirigir varias familias de leucocitos circulantes hacia los si os con daño, también citoquinas proinflamatorias
como factor de necrosis tumoral alfa (TNF-a) (por sus siglas en inglés), IL-1 e IL-6, sin embargo, la ac vación de las células de Küpffer no solo ene un efecto deletéreo, puedenadoptarunfeno poan inflamatoriomediantela (13) liberacióndeIL-10.
Elconsumodealcoholseasociaconunestadode inmunodeficiencia y a la ac vación del sistema inmune (13) queconllevaaldesarrollodelalesiónhepá ca.
Influencia del consumo de alcohol sobre el sistema cardiovascular
En el año 1861, Friedrich L. Goltz, documentó la conexión existente entre la hipertrofia ventricular y el abuso persistente de alcohol. Luego, en 1873, Walter H. Walshe, autor del texto médico, El Diagnós co Físico de las Enfermedades Pulmonares, implementó el término cirrosis cardíaca, para describir los fenómenos de fibrosis observados de forma simultánea en el corazón y en el hígado de pacientes con antecedentes de abuso (14) alcohólico.
Dosisdealcoholcardiotóxica
Una de las primeras inves gaciones que comunican la relación entre la dosis de alcohol y su impacto cardiotóxico fue publicada por Koide y cols. en 1974. Los autores inves garon la asociación entre la dilatación ventricular izquierda en radiogra as de tórax y la dosis de alcohol consumido. En el estudio se arribó a la conclusión que una dosis de etanol puro igual a 125 mL por día se relacionaba con un incremento del índice cardio tóxico (ICT) > 0,5. Se observaron valores de ICT más elevados en el 33 % de los pacientes que bebían una can dadiguala125mLpordíayenel4%delospacientes que bebían entre 75 a 125 mL, así como en 2,9 % de los (15) pacientesquebebíanmenosde75mL.
Hipertensióninducidaporelalcohol
La relación entre el consumo de alcohol y la elevación de la presión arterial puede ser temporal y acabar cuando se cesa de beber esta sustancia. El efecto hipertensivodelalcoholalpareceresindependientedela ac vidad sica, el índice de masa corporal (IMC), el tabaquismo y los antecedentes de hipertensión arterial. (16)

Este efecto es provocado por varios mecanismos que incluyen: crecimiento de la ac vidad del eje reninaangiotensina-aldosterona y del sistema nervioso simpá co, cambios en la sensibilidad de la insulina, aumentodelasecrecióndecor sol,disfunciónendotelial y reducción en la producción de óxido nítrico. La modulación de la ac vidad del sistema nervioso central luegodelaexposiciónalalcoholesunacausaimportante de la elevación de la tensión arterial Los tractos nerviosos que son vulnerables al alcohol son el núcleo intermedio-lateral, el bulbo raquídeo rostrolateral ventral y el reflejo baroreceptor, que pasa por el núcleo (17) solitarioyprovocalareacciónhipertensiva.
Según se expone en las guías de Sociedad Europea de Cardiología para el manejo de la hipertensión, no se recomienda una dosis de alcohol por encima de 14 unidades de alcohol (UA) por semana (una UA con ene10gramosdeetanol)enhombresy8 UA por semanas en mujeres. El aumento de la dosis consumida guarda estrecha relación con el riesgo de padecer (18) hipertensiónarterial.
Miocardiopa adilatada
El predominio de miocardiopa a dilatada en el estudio que se realizó por Fernández y cols. fue más alta entre los pacientes que consumían alcohol en comparación con la población general y alcanzó el 0,43 % en hombres (can dad media de alcohol puro consumido durante toda la vida: 30 ± 7 kg/kg de masa corporal duranteunpromediode29±6años)y0,25%enmujeres (can dadmediadealcoholpuroconsumidodurantetoda la vida: 17 ± 7 kg/kg de masa corporal durante un promediode23±7años),sinembargo,enlapoblaciónla prevalencia de miocardiopa a dilatada alcanza a 1 de cada 2 500 individuos (0,04 %), también, demostró que, en los países occidentales, el abuso de alcohol es la (19,20) principalcausademiocardiopa anoisquémica.
Arritmiasrelacionadasconelalcohol
La fibrilación auricular (FA) es la arritmia más frecuente entre las relacionadas con el alcohol. Larsson demostró que, durante la inges ón crónica del alcohol, un incremento de consumo de 1 UA por día, aumenta el riesgo de FA en un 8 %, según se detalla en su ar culo: Alcohol Consump on and Risk of Atrial Fibrilla on: A Prospec ve Study and Dose-Response Meta-Analysis. Con rela va frecuencia, las arritmias se han observado como resultado de la ingesta de una única dosis alta de alcohol en un empo breve y numerosos autores han mencionado esto como: síndrome del corazón en vacaciones. Este síndrome fue descrito por primera vez por E nger en 1978, en su ar culo: Arrhythmiasandthe Holiday Heart: alcohol-associated cardiac rhythm
disorders El consumo de alcohol de forma crónica se asocia al incremento del riesgo de FA cuando se hace un (21) seguimientoalargoplazo.
El alcoholismo es definido como un patrón bastante problemá co de la inges ón de alcohol. Lleva a un deterioro importante del organismo y la conducta. Su consumo en exceso cons tuye la e ología de múl ples afecciones, entre ellas: el cáncer, las enfermedades respiratorias, gastrointes nales, neurodegenera vas, psicológicas,cardiovascularesyrenales.Laprevenciónde su consumo irresponsable en la actualidad forma parte delasprioridadesdelsectordelasalud.
Los autores declaran la no existencia de conflictosdeinteresesrelacionadosconelestudio.
1. Conceptualización: Chris an Gabriel Acosta Ricachi, Sheila Ive e QuinapantaSerrano,ÁlvaroPaúlMoinaVeloz.
2. Curación de datos: Chris an Gabriel Acosta Ricachi, Sheila Ive e QuinapantaSerrano,ÁlvaroPaúlMoinaVeloz.
3. Análisis formal: Chris an Gabriel Acosta Ricachi, Sheila Ive e QuinapantaSerrano,ÁlvaroPaúlMoinaVeloz.
4. Adquisición de fondos: Esta inves gación no contó con adquisición defondos.
5 Inves gación: Chris an Gabriel Acosta Ricachi, Sheila Ive e QuinapantaSerrano,ÁlvaroPaúlMoinaVeloz.
6.Metodología:Chris anGabrielAcostaRicachi.
7.Administracióndelproyecto:Chris anGabrielAcostaRicachi.
8.Recursos:Chris anGabrielAcostaRicachi,SheilaIve eQuinapanta Serrano,ÁlvaroPaúlMoinaVeloz.
9.So ware:SheilaIve eQuinapantaSerrano.
10.Supervisión:Chris anGabrielAcostaRicachi.
11.Validación:ÁlvaroPaúlMoinaVeloz.
12.Visualización:Chris anGabrielAcostaRicachi.
13. Redacción del borrador original: Chris an Gabriel Acosta Ricachi, SheilaIve eQuinapantaSerrano,ÁlvaroPaúlMoinaVeloz.
14. Redacción, revisión y edición: Chris an Gabriel Acosta Ricachi, SheilaIve eQuinapantaSerrano,ÁlvaroPaúlMoinaVeloz.
1.Mar nez M, Altamirano I, Sánchez S, García L, Sánchez M, Hernández M, et al. Desregulación inmunológica y fisiopatología del consumo de alcoho y la enfermedad hepá ca a cohólica Rev Gastroenterol México[Internet] 2023[c tado 24/3/24];88(1):[aprox.18p.].
D sponible en: h ps://www sc encedirect com/science/ ar cle/p /S0375090623000113?ref=pdf download&fr=RR2&rr=7f7715529d2e2891.
2 Figueroa A, Ruíz JC, Téllez L, Mar n R Enfermedad hepá ca inducida por alcohol Med[Internet] 2020[citado 24/3/24];13(4);[aprox.3p.].Disponibleen:h ps://www.sciencedirect.com/science/ar cle/abs/pii/S0304541220300457.
3.Rodríguez A, Pérez C, Mar nez JJ, Borges K, Mar nez I. Principales consecuencias del alcoholismo en la salud. Rev
Universidad Médica Pinareña[Internet] 2018[citado 24/3/24];14(2):[aprox 9p ] Dispon ble en: h ps://revgaleno.sld.cu/index.php/ump/ar cle/view/282/html.
4.Vriz O Pala ni P Rudski L, Frumento P Kasprzak JD, Ferrara F et al. Right Heart Pulmonary Circula on Unit Response to Exercise in Pa ents with Controlled Systemic Arterial Hypertension: Insights from the RIGHT Heart Interna onal NETwork (RIGHT-NET).JClinMed.2022;11(2):451.
5.PicanoE,CiampiQ,Cor gianiL,ArrudaAM,BorguezanC,deCastroE,etal.TheStressEchoStudyGroupOfTheItalianSociety Of Echocardiography And Cardiovascular Imaging Siecvi. Stress Echo 2030: The Novel ABCDE-(FGLPR) Protocol to Define the FutureofImaging.JClinMed.2021;10(16):3641.
6.Hamala P, Kasprzak JD, Binkowska A, Zawitkowska K, Broncel M, Piekarska A, et al. The impact of chronic alcohol overuse on heartfunc onandprognosis:layer-specificlongitudinalstrainandmid-termoutcomeanalysis.KardiolPol.2021;79(7-8):781-8
7.Orphanou N, Papatheodorou E, Anastasakis A. Dilated cardiomyopathy in the era of precision medicine: latest conceptsand developments.HeartFailRev 2022;27(4):1173-91.
8.Nápoles MB, Amaró MA Abreu L, Álvarez CR, Carrazana K, Pereira AL Caracterís cas clínico epidemiológicas de pacientes conenfermedadporhígadograsonoalcohólico:Seriedecasos.GacMédEspirit[Internet].2023[citado24/3/24];25(2):[aprox. 15p.].Disponibleen:h ps://revgmespirituana.sld.cu/index.php/gme/ar cle/view/2528/pdf
9.Vera JE. Transaminasas hepá cas como predictor de diagnós co temprano de esteatosis en usuarios entre 5 y 14 años con sobrepeso y obesidad que acuden al servicio de pediatría del Hospital San Vicente de Paúl de la ciudad de Ibarra durante febrero a junio 2017[Internet]. Quito: PUCE;2017[citado 24/3/24]. Disponible en: h ps://repositorio.puce.edu.ec/server /api/core/bitstreams/a2b73945-8b96-4192-bee3-717ed7d2cb4b/content.
10.MéndezN,ArreseM,GadanoA,Oliveira CP,FassioE,Arab JP etal.TheLa nAmericanAssocia onfortheStudyoftheLiver (ALEH)posi onstatementontheredefini onoffa yliverdisease.LancetGastroenterolHepatol.2021;6(1):65-72.
11.Castellanos MI Crespo E, del Valle S, Barreto E, Díaz JO, Santaló L, et al. Non-Alcoholic Fa y Liver Disease in Cuba. Medicc Review 2021;23(1):64-71.
12.Sahuquillo A, Ramírez JI Torres MP Solera J Tárraga PJ La ecogra a, técnica diagnós ca en esteatosis hepá ca no
h ps://scielo.isciii.es/pdf/jonnpr/v5n4/2529-850X-jonnpr-5-04-392.pdf
13.ArabJP DirchwolfM,Álvares-da-SilvaMR BarreraF BenítezC,CastellanosM,etal.La nAmericanAssocia onforthestudy of the liver (ALEH) prac ce guidance for the diagnosis and treatment of nonalcoholic fa y liver disease. Ann Hepatol. 2020;19(6):674-90.
14.BreaA,PuzoJ.Non-alcoholicfa yliverdiseaseandcardiovascularrisk.IntJCardiol.2013;167(4):1109-17.
15.Tirdea C, Hos uc S, Moldovan H, Scafa A. Iden fica on of Risk Genes Associated with Myocardial Infarc on-Big Data AnalysisandLiteratureReview IntJMolSci.2022;23(23):15008.
16.Arroyave JC, Wu Z, Geng Y, Moshage H. Role of oxida ve stress in the pathogenesis of non-alcoholic fa y liver disease: Implica onsforpreven onandtherapy An oxidants.2021;10(2):174.
17.Ghoneim S, Dhorepa l A, Shah AR, Ram G, Ahmad S, Kim C, et al. Nonalcoholic steatohepa s and the risk of myocardial infarc on:Apopula on-basedna onalstudy WorldJHepatol.2020;12(7):378-88.
18.Soares MC, Montemezzo M, Precoma DB, de Noronha L, Kluthcovsky AC, Lipinsky L, et al. The rela onship between nonalcoholicfa yliverdiseaseandacutecoronarysyndromeseverity:isnon-alcoholicfa yliverdiseaseariskmarkerofcoronary atherosclero cdisease,EuropeanHeartJournal.2021;42(1):1449.
19.Hui L, Cao Y, Sun D, Jin J, Guo Y, Wu N, et al. Impact of Non-Alcoholic Fa y Liver Disease on Cardiovascular Outcomes in Pa ents with Stable Coronary Artery Disease: A Matched Case Control Study Clinical and Transla onal Gastroenterology 2019;10(2):e00011.
20 Hidalgo H, Suárez B, Belaunde A, Cardoso D. Síndrome cardiohepá co en pac entes con insuficiencia cardiaca descompensadaenelHospitalMilitarCentral“Dr CarlosJ.Finlay” ActaMédica[Internet].2021[citado24/3/24];22(4):[aprox. 4p.].Disponibleen:h ps://revactamedica.sld.cu/index.php/act/ar cle/view/244.
21.Chung G, Cho E, Yoo J, Chang Y, Cho Y, Park S, et al. Young Adults with Nonalcoholic Fa y Liver Disease defined using Fa y Liver Index can be at increased Risk for Myocardial Infarc on or Stroke Diabetes Obesity and Metabolism. Diabetes Obes Metab.2021;24(3):465-72.


El siguiente reporte clínico es de una pacientes de 70 años que experimentó efectos adversos graves debido al tratamiento con metotrexato, incluyendo anemia y disminución de glóbulosblancos yplaquetas.
1 2 Marisol Silva-Vera , Xochi l Viridiana Piña-Padilla , 1 María de Jesús Jiménez-González y Raúl Fernando 1Guerrero-Castañeda
1 División de Ciencias de la Salud e Ingenierías, Campus Celaya-Salva erra.UniversidaddeGuanajuato
2 Consultorio Médico Biovida Salud, Acámbaro, Guanajuato
Correspondencia:msol78@gmail.com
Fuente: Rev Med Clin 2024;8(1): e28052408009. DOI: 10.5281/zenodo.13763510
Antecedentes: Los pacientes con artri s reumatoide (AR) tratados con metotrexato (MTX) presentar mielosupresión, leucopenia, trombocitopenia y anemia megaloblás ca La toxicidad hematológica provoca que los pacientes interrumpan el tratamiento debidoalriesgodemortalidad.
Caso clínico: Paciente femenino de 70 años con diagnós co de AR, acude con astenia, adinamia, fiebre nocturna y dolor en la mucosa oral; con hemoglobina de 7.5g/dL, leucocitos 1700µl y plaquetas de 13,000/mm3. La paciente es diagnos cada con mielosupresión secundaria a MTX se maneja con hemoderivados, hidratación,ácidofolinico,factores muladordecolonias de granulocitos rHu-G-CSF y glicopreoteina recombinante.
Conclusiones: El MTX es eficaz en el tratamiento de la AR, su uso indebido, en adultos mayores, puede causar efectos secundarios graves, como toxicidad hematológica y riesgo de infecciones. El manejo de la mielosupresión secundaria a MTX ene tres obje vos, eliminación del metotrexato del torrente sanguíneo, terapia con ácido folínico y tratamiento enfocado en la pancitopenia.
Palabras clave: Mielosupresión, metotrexato, artri s reumatoide

El metotrexato (MTX) es un análogo del folato, actúa inhibiendo a la enzima dihidrofolato y por lo tanto se disminuyen las reservas de la enzima tetrahidrofolato reductasa; el bloqueo efec vo de la síntesis de la enzima tetrahidrofolato por el metotrexato conduce a la incapacidad de las células para dividirse y producir proteínas, ya que el folato reducido a tetrahidrofolato es precursor de las bases nitrogenadas que forman la estructura del ADN y el ARN Además, interviene en las reacciones de me lación, así como de replicación y 1 síntesisdelADN.
Diversas líneas de inves gación sugieren que el metotrexato no actúa únicamente como un agente citotóxico y an - prolifera vo contra las células responsables de la inflamación ar cular en patologías como la artri s reumatoide (AR) Actualmente el mecanismo de acción del MTX sobre la disminución de la inflamación y la proliferación de las células del sistema 2inmune a concentraciones efec vas administrándolo 3 una vez a la semana con nua como objeto de estudio. Igualmente, la rápida remisión clínica y el efecto a corto plazo sobre los reactantes de fase aguda, como se observaalad-ministrardosisbajasde MTX enlamayoría 4 delospacientesconARtambiénrequiereinves garse.
En 1988, la Food and Drug Administra on (FDA) aprobó al MTX como un tratamiento para la AR El MTX se puede combinar con otros fármacos an rreumá cos 5 modificadores de la enfermedad biológica (FARME). Aunque pocos estudios sugieren algún efecto específico delMTXsobreelnúmeroolafuncióndeloslinfocitosTen 6 pacientes con AR, el MTX ejerce efectos inhibidores 7 8 9 claros in vivo e in vitro sobre los neutrófilos y par cularmente sobre los monocitos/macrófagos que se cree que enen un papel central en la fisiopatología de la 10AR.
Los efectos secundarios del MTX son superados por su efec vidad, ya que sus efectos nega vos se 11 12 reflejan en el hígado, los pulmones, la microbiota 13 14 15 intes nal, la medula ósea y el riñón. Existe una gran variabilidad en la prác ca clínica tanto en el sector público como privado, respecto a la dosis de inicio, la velocidadypautadeescaladodelasdosis,seleccióndela vía de administración y dosificación en el uso concomitante del ácido fólico o folínico en pacientes con 16 AR
Una dosis alta de MTX se define como una dosis superior a 500mg/m2, comúnmente esta dosis se u liza para tratar diferentes pos de cáncer Aunque a dosis altas se administra de forma segura a la mayoría de los pacientes, esta dosis les puede causar toxicidad
significa va. Las indicaciones internacionales basadas en la evidencia establecen que el MTX oral debe iniciarse con 10 a 15mg/semana, con una escala- da de 5mg cada dosacuatrosemanashasta20mg/semana,dependiendo de la respuesta clínica y la tolerabilidad.17 Sin embargo, 18 diversos ensayos clínicos con MTX en AR señalan que una de las complicaciones más temidas debido a su alta 19 morbilidadymortalidadeslamielosupresión.
Paciente femenina de 70 años, ama de casa, sin anteceden- tes heredofamiliares de importancia. Refiere presenciadeHipertensiónArterialde6añosdeevolución tratadaconlosartan/hidrocloro azida100/25mgcada12 hrs, Hipo roidismo de 4 años de evolución tratada con levo roxina 100mg/día, Artri s reumatoide de 28 años de evolución tratada con AINES, esteroides y MTX 7.5 a 10mg/semana. Negó exposición a solventes, químicos, hidrocarburos, fer lizantes, insec cidas, tabaquismo, alcoholismo,asícomotransfusiones.
Refiere consumo de medicamentos de forma crónica como AINES, metotrexato y dexametasona secundario a AR Ha presentado frecuentemente episodiosdedolorar cular,estreñimientoydiarrea.Sele diagnos có previamente salmonelosis la cual se manejó con trimetoprima/sulfametoxazol, analgésicos y an espasmódico presentando mejoría transitoria respectoaladiarrea.
La paciente acude al área de urgencias con astenia, adinamia, fiebre nocturna y dolor en la mucosa oral.Niegahemorragiasacualquiernivel.
A la exploración sica paciente se observa cronológica- mente edad a la aparente, neurológicamente integra, signos vitales dentro de parámetros normales, febril 38°C, palidez mucocutánea ++++, mucosa oral eritematosa, zona peribucal con edema +++ y presencia de ulceras bucales, cuello simétrico, sin presencia de adenomegalias, cardiorespiratorio sin compromiso, abdomen ligeramente distendido, no hepatomegalia ni esplenomegalia, peristalsis aumentada, giordano nega vo, no edema de extremidades inferiores, niega alteración de los es nteres.Niegadoloreinflamaciónenar culacionesde extremidadessuperiores,deformidadendorsodemanos caracterís casdeAR.
La biometría hemá ca inicial reportó: Hemoglobina 7.5g/dL, hematocrito 22.4 %, eritrocitos 2.3x106/µl, VGM 105.2fL, HGM 36.2pg, re culocitos 8.5 x 103µl, plaquetas 13000/mm3, leucocitos 1700µl, neutrófilos totales 971µl, linfocitos 596µl Fro s: Respecto a la serie roja se observó microcitosis +++,
macrocitosis++ Hipocromía+++ Respecto a la serie blanca se observó leucopenia con presencia de mul lobulación de neutrófilos y linfopenia. Respecto a la serie plaquetaria se observó trombocitopenia (Figura 1).
Paraclínicos: Panel Viral VIH (-), VHC (-), VHB (-), VEB (-), CMV (-). Vitamina B12 40 pg/ml, Ácido fólico 6000.00 ng/ml. Deshidrogenasa lác ca 190 U/L; bilirrubina directa 0 16mg/dl; bilirrubina indirecta 0 41mg/dl; bilirrubina Total 0.57mg/dl; proteínas totales 5.1g/dl; albúmina 4.23 g/dl; TGO 54.0U/L; TGP 58.0U/L; GGT 21 U/L; fosfatasa alcalina 193U/L; ácido úrico 8.9mg/dL, electrolitos séricos normales. Examen general de orina sin patología o datos de hematuria, sangre oculta en hecesnega va.PruebaCOVIDnega va.
Figura1:Fro sdeSangrePeriférica,Respectoala serie roja se observó macrocitosis++. Respecto a la serie blanca se observó mul lobulación de neutrófilos Respecto a la serie plaquetaria se observó trombocitopenia.
Imagen: Ultrasonido abdominal sin presencia de datos de hepatomegalia ni esplenomegalia. Tele de tórax sinalteraciones.
Se inicia manejo con hidratación, analgésico, profilaxis an micó ca, an viral y an bacteriana, alopurinol, así como hema nicos IV, además de an micó coencolutorios;previatomadehemocul voy urocul vo.Seindican7concentradosplaquetariosprevio protocolo en Banco de Sangre Los niveles de

hemoglobina a las 24 horas de la toma inicial se reportaronen6.5g/dlyelhematocritoen16%porloque se inician 2 paquetes globulares hemo po O Rh posi vo, los cuales se administran sin complicaciones. La paciente se reporta con mejoría clínica, aún persiste astenia y adinamia, sin fiebre, sin datos de hemorragias ac vas, evacuaciones presentes no diarreicas, disminución del eritema en la mucosa oral y tolerando vía oral de manera adecuada.
Una vez con los valores de hemoglobina en 8 5g/dl, se agrega al manejo factor es mulador de colonias de granulocitos rHu-G-CSF y glicopreoteina recombinante,elaspiradodemedulaóseasereportacon morfología normal, cul vos sin presencia de crecimiento bacteriano. Termina esquema de profilaxis. Actualmente la paciente se reporta estable, se ajusta dosis de MTX a 7.5mg/semana, así como ácido fólico de 5mg vía oral sin suspender
El MTX reduce la inflamación por un mecanismo relacionadoconelmetabolismodelácidofólicoyaquede manera irreversible inhibe a la enzima dihidrofolato reductasa, por lo tanto, se interfieren los procesos de síntesis de proteínas, de reparación y replicación celular del ADN que ocurren en las células de la medula ósea, que es un tejido de alta proliferación fisiológica, con una 2 altasensibilidadalosefectosdelMTX
Unestudiomostróqueel MTX inhibelaac vidad 21 delascélulasT; ysesabequelosmetabolitosdelMTXse acumulan en tejidos como el hígado y los eritrocitos, durante un período prolongado y pueden ser detectados 22 hasta24horasdespuésdesuspendereltratamiento. De manera interesante, una dosis baja por empo prolongado puede causar toxicidad en la médula ósea o 23 en el epitelio gastrointes nal. Lo anterior citado explica gran parte de la sintomatología pre- sentada por la paciente, como la anemia, linfopenia, trombocitopenia, aumentodelastransaminasas,ulcerasoralesyladiarrea.
Diversos factores de riesgo relacionados con la paciente pudieron aumentar el riesgo de 24mielosupresión. La depleción de volumen es posiblemente el riesgo más importante y puede ser el resultado de pérdidas de líquido debido a vómito y/o diarrea.Losfactoresadicionalesquepresentalapaciente contribuyenalriesgodemielosupresiónestospuedenser nefropa a preexistente debido a toxicidad previa de algúnfármaco,25presenciadeenfermedadcrónica,trastornos metabólicos, edad avanzada y factores 26farmacogené cos. Otros factores de riesgo de toxicidad hematológica descritos son hipoalbuminemia, deficiencia de ácido fólico, infecciones agudas y el uso
concomitante de MTX con fármacos como el probenecid 27 y trimetoprima/sulfametoxazol. Es probable que la combinación del MTX con trimetoprima/sulfametoxazol podría haber causado la precipitación de pancitopenia, yaquelosvaloresdeleucocitosseencontrabannormales 90 días antes del tratamiento con an bió co, lo anterior asociadoconlapresenciadeenfermedadcrónica.
En algunos pacientes tratados con MTX puede exis rundéficitdeácidofólico,porloquelaprescripción de ácido fólico o folínico puede mejorar la tolerancia y seguridad del MTX La suplementación de ru na con ácido fólico/folínico no afecta en general la eficacia del MTX, aunque los datos de un estudio sugieren que el uso de estos suplementos podría con llevar un aumento 28 ligerodeladosisdeMTXparamantenerlaeficacia.
En conclusión, los pacientes con AR, especialmente aquellos adultos mayores con enfermedades crónicas y que se manejan con una combinación de MTX y AINES, deben mantenerse adecuadamente monitoreados en especial si coexisten otras enfermedades crónicas y presentan infecciones agudasquerequieranan bio coterapia.
RESPONSABILIDADESÉTICAS
Los autores declaran que para esta inves gación nosehanrealizadoexperimentosensereshumanosnien animales.
El financiamiento del trabajo fue cubierto por los autores.
CONFLICTODEINTERÉS
Los autores niegan presentar conflictos de interésenestetrabajo
REFERENCIAS
1CutoloM,SulliA,PizzorniC,SerioloB,Straub RH An -inflammatory mechanismsofmethotrexateinrheumatoidarthri s.AnnRheumDis. 2001;60(8):729-735.doi:10.1136/ard.60.8.729.
2 Bedoui Y, Guillot X, Sélambarom J, Guiraud P, Giry C, et al. Methotrexate an Old Drug with New Tricks. Int. J Mol. Sci.2019; 20:5023.doi:10.3390/ijms20205023.
3 Lucas CJ, Dimmi SB, Mar n JH Op mización de dosis bajas de metotrexatoparalaartri sreumatoide-Arevisión.H.JClinPharmacol. 2019;85(10):2228-2234.doi:10.1111/bcp.14057.
4 Maksimovic V, Pavlovic-Popovic Z, Vukmirovic S, et al. Molecular mechanism of ac on and pharmacokine c proper- es of
methotrexate Mol Biol Rep 2020;47(6):4699-4708 doi:10.1007/s11033-020-05481-9.
5 Burmester, Gerd R., et al. Adalimumab alone and in com- bina on with disease-modifying an rheuma c drugs for the treatment of rheumatoid arthri s in clinical prac ce: the Re- search in Ac ve Rheumatoid Arthri s (ReAct) trial. Annals of the rheuma c diseases 66.6(2007):732-739.
6 Xu M, Wu S, Wang Y, et al Associa on between high- dose methotrexate-induced toxicity and polymorphisms within methotrexate pathway genes in acute lymphoblas c leukemia. Front Pharmacol.2022;13:1003812.doi:10.3389/fphar.2022.1003812.
7 Friedman B, Cronstein B. Methotrexate mechanism in treatment of rheumatoid arthri s Joint Bone Spine 2019;86(3):301-307 doi: 10.1016/j.jbspin.2018.07.004.
8 Correal ML, Camplesi AC, Anai LA, Bertolo PHL, Vascon- celos RO, Santana ÁE ToxicityofamethotrexatemetronomicscheduleinWistar rats.ResVetSci.2020;132:379-385.doi:10.1016/j.rvsc.2020.07.015.
9 Kaundal U, Khullar A, Leishangthem B, et al The effect of methotrexate on neutrophil reac ve oxy- gen species and CD177 expression in rheumatoid arthri s Clin Exp Rheumatol 2021;39(3):479-486.doi:10.55563/clinexprheumatol/4h5onh
10 Reiss AB, Teboul I, Kasselman L, Ahmed S, Carsons SE, De Leon J Methotrexate effects on adenosine receptor expression in peripheral monocytesofpersonswithtype2diabetesandcardiovasculardisease. JInves gMed.2022;70(6):1433-1437.doi:10.1136/jim-2022-002355.
11 Azadnasab R., Kalantar H., Khorsandi L., Kalan- tari H., Khodayar M.J Epicatechin Ameliora ve Effects on Methotrexate-Induced Hepatotoxicity in Mice. Hum. Exp. Toxicol. 2021;40:S603–S610.doi:10.1177/09603271211047924.
12 Kim Y -J , Song M , Ryu J -C Mechanisms Underlying Methotrexate-Induced Pulmonary Toxicity ExpertOpin.DrugSaf 2009;8:451–458.doi:10.1517/14740330903066734.
13 Letertre M.P.M., Munjoma N., Wolfer K., Pechlivanis A., McDonald J.A.K., HardwickR.N.,CherringtonN.J.,CoenM.,NicholsonJ.K.,Hoyles L., et al. A Two-Way Interac on between Methotrexate and the Gut Microbiota of Male Sprague–Dawley Rats. J Proteome Res. 2020; 19:3326–3339.doi:10.1021/acs.jproteome.0c00230.
14 Feinsilber D., Leoni R.J., Siripala D., Leuck J., Mears K.A. Evalua on, Iden fica on, and Management of Acute Metho- trexate Toxicity in High-DoseMethotrexateAdministra oninHematologicMalignancies. Cureus.2018;10:e2040.doi:10.7759/cureus.2040.
15 Ramalanjaona B., Hevroni G., Cham S., Page C., Salifu M.O., McFarlane S I Nephrotoxicity Associated with Low- Dose Methotrexate and Outpa ent Parenteral Microbial Therapy: A Case Report, Review of the Literature and Pathophysiologic Insights. Am. J Med.CaseRep.2020;8:400–404.doi:10.12691/ajmcr-8-11-6.
16 Tornero Molina J, Ballina García FJ, Calvo Alén J, et al Recommenda ons for the use of methotrexate in rheumatoid arthri s: up and down scaling of the dose and administra on routes. ReumatolClin.2015;11(1):3-8.doi:10.1016/j.reuma.2014.02.012.
17 Smolen JS, Landewe R, Breedveld FC, Buch M, Bur- mester G, Dougados M, et al. EULAR recommenda ons for the management of rheumatoid arthri s with synthe c and biological disease-modifying an rheuma c drugs: 2013 update Ann Rheum Dis 2014;73(3):492–509.10.1136/annrheumdis-2013-204573.
18 Lim AY, Gaffney K, Sco DG. Methotrexate-induced pancytopenia:
serious and under-reported? Our experience of 25 cases in 5 years. Rheumatology 2005;44(8):1051–1055.
19 Aris zabal-Alzate A, Nieto-Rios JF, Ocampo-Kohn C, Serna- Higuita LM, Bello-Marquez DC, Zuluaga-Valencia GA Successful mul pleexchange peritoneal dialysis in a pa ent with severe hematological toxicity by methotrexate: case report and literature review J Bras Nefrol.2019;41(3):427-432.doi:10.1590/2175-8239-JBN-2018-0095.
20 Prey S, Paul C. Effect of Folic or Folinic Acid Supplementa on on Methotrexate-Associated Safety and Efficacy in In- flammatory Disease: A Systema c Review. Br. J. Dermatol. 2009; 160:622–628. doi:10.1111/j.1365-2133.2008.08876.x.
21 Zhang Y, Liu P, Li Y, Zhang A. Explora on of metabolite signatures using high-throughput mass spectrometry coupled with mul variate dataanalysis.RSCAdv 2017;7:6780-6787.doi:10.1039/C6RA27461G.
22 Dalrymple JM, Stamp LK, O'Donnell JL, Chapman PT, Zhang M, Barclay ML Pharmacokine cs of oral methotrexate in pa ents with rheumatoid arthri s. Arthri s Rheuma sm: Official Journal of the American College of Rheumatology 2008;58(11):3299-3308 doi:10.1002/Art.24034.
23 Chabner BA, Young RC. Threshold methotrexate concentra on for in vivo inhibi on of DNA synthesis in normal and tumorous target ssues.JClinInvest.1973;52(8):1804-1811.doi:10.1172/JCI107362.
24 Feinsilber D, Leoni RJ, Siripala D, Leuck J, Mears KA Evalua on, Iden fica on, and Management of Acute Methotrexate Toxicity in High-doseMethotrexateAdministra oninHematologicMalignancies. Cureus 2018;10(1): e2040 Pu- blished 2018 Jan 8 doi:10.7759/cureus.2040.
25 Howard SC, McCormick J, Pui CH, Buddington RK, Har- vey RD. Preven ng and Managing Toxici es of High- Dose Methotrexate.
O n c o l o g i s t 2 0 1 6 ; 2 1 ( 1 2 ) : 1 4 7 1 - 1 4 8 2 doi:10.1634/theoncologist.2015-0164.
26 Chiusolo P, Giammarco S, Bellesi S, et al. The role of MTHFR and RFC1 polymorphisms on toxicity and outcome of adult pa ents with hematological malignancies treated with high-dose methotrexate followed by leucovorin rescue. Cancer Chemother Pharmacol. 2012; 69:691–696.
27 Al-Quteimat OM, Al-Badaineh MA Methotrexate and trimethoprim-sulphamethoxazole: extremely serious and lifethreatening combina on. J Clin Pharm Ther 2013;38(3):203- 205. doi:10.1111/jcpt.12060.
28 Tornero Molina J, Ballina García FJ, Calvo Alén J, Caracuel Ruiz MA, et al. Recomendaciones para el uso del metotrexato en artri s reumatoide:incrementoyreduccióndedosisyvíasdeadministración.
R e u m a t o l o g í a C l í n i c a 2 0 1 5 ; 1 1 ( 1 ) : 3 - 8 h ps://doi.org/10.1016/j.reuma.2014.02.012.
EDUCACIÓN A DISTANCIA
Actualización en Hemostasia y Coagulación
Inscripción: permanente
Organiza: UNL (Universidad Nacional del Litoral)
E-mail: formacioncontinua@ cb.unl.edu.ar
Web: www. cb.unl.edu.ar
Bioquímica Clínica de los Líquidos y Electrolitos
Inscripción Permanente
Organiza: UNL (Universidad Nacional del Litoral)
E-mail:
formacioncontinua@ cb.unl.edu.ar
Web: www. cb.unl.edu.ar/app/cursos
Especialización en Bioquímica Clínica en área de Microbiología
Modalidad: online
Organiza: Universidad Nacional de La Rioja
Email: posgrado.dacefyn@unlar.edu.ar
Especialización en Endocrínologia
Fecha: 2024 Caba Argentina
Organiza: UBA Universidad de Buenos
Aires
Info: posgrado@ffyb.uba.ar
Mutagénesis y Caracterización Funcional deProteínasExpresadasenCélulas
2024 CABA Argentina Organi-za UBA (UniversidaddeBuenosAires) posgrado@ffyb.uba.ar
NuevasEstrategiasdeDiagnósticoyTratamientodelaEnfermedadvascular
2024 CABA Argentina Organiza UBA (UniversidaddeBuenosAires) posgrado@ffyb.uba.ar
CursosobreMicologíaMédica
Inscripcionesabiertas
OrganizaFundaciónQuímicaArgentina info@fundacionquimica.org.ar
EndocrinopatíasyEmbarazo
Contarán con 120 días para completar el curso
Organiza SAEGRE (Sociedad Argentina de Endocrinología Ginecológica y Reproductiva)
congresosaegre@gmail.com http://saegre.org.ar/curso_online_endocri nopatias.asp
CursodeBiologíaMolecular
Organiza FQA (Fundación Química Argentina)
info@fundacionquimica.org.ar
Mutagénesis y Caracterización Funcional de Proteínas Expresadas en Células
Lugar:CABA Argentina
Organiza: UBA (Universidad de Buenos Aires)
Email:posgrado@ffyb.uba.ar
Maestría en Investigación Clínica
2024
CABA, Argentina
Organiza Hospital Universitario Italiano de Buenos Aires
maestriasydoctorados@hospitalitaliano.o rg.ar
https://maestrias.hospitalitaliano.edu.ar/i nvestigacionclinica
XXIV IFCC - EFLM Euromedlab Munich
2021
Lugar: Munich Alemania
Email: info@rwgroup.com.ar
AACB 58TH ANNUAL SCIENTIFIC CONFERENCE
Lugar: Brisbone Australia
Email: conference@aacb.asn.au
Web:
http://www.euromedlab2021munich.org/
Biología de emergencia y gases en sangre
2024 Saint Malo Francia
cbardin@terresetcie.com
AADEE S.A.
Av. Triunvirato 4135 5° Piso (1431)
Ciudad Autónoma de Buenos Aires
Te: 54-11-4523-4848
Fax: 54-11-4523-2291 www.aadee.com.ar
Avan
Padre M. Ashkar N°688 - (CP 1672) Gral San Martin, Bs
As - Argentina
Tel: (54 11) 47542168 rot - Wpp: +54 911 6228 4796 Web: www.avan.com.ar - info@avan.com.ar
Becton Dickinson Argentina S.R.L.
Av. Libertador 110 P.2 (1638)
Vicente Lopez, Buenos Aires
Tel: (54 11) 4718 7900 - 0800 444 55 BD (23) crc_argentina@bd.com www.bd.com
Bernardo Lew info@bernardolew.com.ar
0291 450 0715
+54 9 291 575 8330 https://www.bernardolew.com.ar
BIOARS S.A.
Estomba 961 (1427)
Ciudad Autónoma de Buenos Aires
Tel./Fax (54 11) 4771-7676/ 3783 pl@bioars.com.ar www.bioars.com.ar
Biocientífica S.A.
Iturri 232 ( 1427)
Ciudad Autónoma de Buenos Aires
Tel: (54-11) 4857-5005
Fax: (54-11) 4857-1004 - ventas@biocientifica.com.ar www.biocientifica.com.ar
Biodiagnostico S.A.
Av. Ing. Huergo 1437, PB (1107)
Ciudad Autónoma de Buenos Aires
Tel/fax: (54 11) 4300 9090 info@biodiagnostico.com.ar www.biodiagnostico.com.ar
Bg Analizadores S.A
Casa Central Aráoz 86 I CABA
C1414DPB I Argentina
Tel.: +54 11 4856 2024 ventas@bganalizadores.com.ar www.bganalizadores.com.ar www.linkedin.com/in/bg-analizadores-sawww.instagram.com/bganalizadores/
Neuquén
Santa Cruz 1529 I Neuquén
Oficina Comercial Bahía Blanca
1 de Marzo 993 PB A I Bahía Blanca
Tel.: +54 299 447 1385 / +54 299 448 7289 bganqn@bganalizadores.com.ar
Bahía Blanca
San Luis 63 | Bahía Blanca | 8000 | Argentina
Tel.: +54 9 291 441 9072 bgabb@bganalizadores.com.ar
Cromoion SRL
Central: Oporto 6125 - Ciudad de Buenos AiresArgentina
Planta Elaboradora Punta Alta, Prov. de Buenos Aires mail: reporte@cromoion.com website: www.cromoion.com
Tel: +54 11 4644-3205/06
WhatsApp +54 9 11 4141-4365 Instagram @cromoion
Cisma Laboratorios S.A
San Lorenzo 158, Tres Arroyos, Buenos Aires Arg. Tel: (+54) 2893 15406395 (+54) 2893 420867
Web: cismalab.com.ar
Emai: cismalab@cismalab.com.ar
Coya Sistemas SRL
Tel: (+54 0342) 455-1286 / 456-4842 / 417-2692
Iturraspe 2246,Santa Fe Email: info@coyasistemas.com.ar
Diagnos Med S.R.L.
Conesa 859 (1426)
Ciudad Autónoma de Buenos Aires
Tel: (54 11) 4552 2929 info@diagnosmed.com www.diagnosmed.com
ETC Internacional S.A.
Allende 3274 (1417)
Ciudad Autónoma de Buenos Aires
Tel: (54 11) 4639 3488 (líneas rotativas)
Fax: (54 11) 4639 6771 etcventa@etcint.com.ar www.etcint.com.ar
Gematec S.R.L.
Avalos 3651 (1605)
Munro - Buenos Aires
Tel: (54 11) 4794 7575 / 7676
Fax: (54 11) 4794 3184 info@gematec.com.ar ventas@gematec.com.ar
Genetrics S.A. - NextLAB
Av. del Libertador 8630 6to piso Of. 1 y 2 (1429 entrar así a baja cdad) - Ciudad de Buenos Aires
Tel. (54 11) 5263 0275 rotativo
E-mail: info@nextlab.com.ar web: www.nextlab.com.ar
GLYM SOFTWARE S.R.L
Piedras 519 - 8- A, Capital Federal, República
Argentina
Tel: Capital : +54 (011) 43314512 -- Mendoza + 54 (261) 4762331 - Córdoba +54 (351) 5685715 - Bahia Blanca + 54 (291) 4851101 administracion@glyms.com
JS Medicina Electrónica SRL
Bolivia 460 (1603)
Villa Martelli, Buenos Aires
Tel : 4709-7707 4709-7677 4709-1131
Fax: 4709-7707 info@jsweb.com.ar www.jsweb.com.ar
IACA LABORATORIOS
- San Martín 68, Galería Plaza (8000)
Bahía Blanca - Buenos Aires
Tel: (54 291) 459 9999
Fax: (54 291) 459 9996 / 8
- Suipacha 1322 PB “B”
Ciudad Autónoma de Buenos Aires
Tel/Fax: (54 11) 4327 2602 / 4326 1806 laboratorios@iaca.com.ar www.iaca.com.ar
I.B INSTRUMENTAL BIOQUÍMICO S.A
Venezuela 3755, Villa Martelli B1603BTM - Buenos Aires, Argentina www.instrumental-b.com.ar
Laboratorio de Medicina
Olaya 1644 (1414)
Ciudad Autónoma de Buenos Aires
Tel: 47087400 - Wpp: 1132647777 info@labmedicina.com www.labmedicina.com
Laboratorio Bacon
Uruguay 136 (1603)
Villa Martelli, Buenos Aires
Tel: (54 11) 4709 0171 bacon@bacon.com.ar www.bacon.com.ar
MANLAB
Marcelo T. de Alvear 2263 (1122)
Ciudad Autónoma de Buenos Aires
Tel: (54 11) 6842 1200 derivaciones@manlab.com.ar www.manlab.com.ar
Meganalizar
Cede Laboratorio: Montecaseros 2478 (5500) Mendoza
Tel. (54 261) 4373241/42 mega@analizar-lab.com.ar Administración: Belgrano 925 (5500) Mendoza
Tel. (54 261) 4236647/9125/9333 gerencia@abm.org.ar
Montebio S.R.L.
Vera 575, Ciudad Autonoma de Buenos Aires
Tel/fax: (54 11) 4858 0636 info@montebio.com.ar www.montebio.com.ar
Stamboulian Laboratorio
Av. Scalabrini Ortiz 676 (1414)
Ciudad Autónoma de Buenos Aires
Tel: (54 11) 4858-7000 laboratorio@stamboulian.com.ar www.stamboulian.com.ar
Wiener lab
Casa Central: Riobamba 2944 Rosario-Argentina
Tel: 543414329191
Web: wiener-lab.com.ar servicioalcliente@wiener-lab.com
Proveedores generales por especialidades bioquímicas
Autoinmunidad
Abbott Rapid Diagnostics
Biocientífica S.A.
Biodiagnostico S.A.
Diagnos Med S.R.L.
ETC Internacional S.A.
Bacteriología
Abbott Rapid Diagnostics
Becton Dickinson Argentina S.R.L.
Biodiagnostico S.A.
Britania S.A.
ETC Internacional S.A.
Montebio S.R.L.
ONYVA SRL
Bg Analizadores
Biología Celular
Becton Dickinson Argentina S.R.L.
BIOARS S.A.
Biocientífica S.A.
ETC Internacional S.A.
Montebio S.R.L.
Tecnolab s.a.
Biología Molecular
Abbott Rapid Diagnostics
Becton Dickinson Argentina S.R.L.
BIOARS S.A.
Biocientífica S.A.
Biodiagnostico S.A.
Diagnos Med S.R.L.
ETC Internacional S.A.
Laboratorios Bacon S.A.I.C.
Montebio S.R.L.
Siemens Healtcare
Tecnolab s.a.
Cromoion SRL
Bg Analizadores
Birología
B.G Analizadores S.A
Bromatología
Becton Dickinson Argentina S.R.L.
Biocientífica S.A
Clínica General AADEE S.A.
Abbott Laboratories Argentina S.A.
Biodiagnostico S.A.
JS Medicina Electrónica SRL
I.B Instrumental Bioquímico S.A
Montebio S.R.L.
Roche Diagnostics Argentina
Siemens Healtcare
Cromoion SRL
Biocientífica S.A
Bg Analizadores
Cultivo Celular
Becton Dickinson Argentina S.R.L.
ETC Internacional S.A.
Endocrinología
AADEE S.A.
Abbott Laboratories Argentina S.A.
Abbott Rapid Diagnostics
BIOARS S.A.
Biodiagnóstico S.A.
Diagnos Med S.R.L.
Laboratorios Bacon S.A.I.C.
Montebio S.R.L.
ONYVA SRL
Roche Diagnostics Argentina
Siemens Healtcare
Cromoion SRL
Bg Analizadores
Genética
Becton Dickinson Argentina S.R.L.
Biocientífica S.A.
Biodiagnostico S.A.
Montebio S.R.L.
Tecnolab s.a.
Gas en sangre y electrolitos
B.G Analizadores S.A
Hematología
AADEE S.A.
Abbott Laboratories Argentina S.A.
Abbott Rapid Diagnostics
BIOARS S.A.
Biocientífica S.A.
Biodiagnostico S.A.
ETC Internacional S.A.
Gematec S.R.L.
Instrumental Bioquímico S.A.
Montebio S.R.L.
ONYVA SRL
Roche Diagnostics Argentina
Siemens Healtcare
Tecnolab s.a.
Bg Analizadores
Histocompatibilidad
Biocientífica S.A.
Biodiagnostico S.A.
B.G Analizadores S.A
Cromoion SRL
Inmunología
Abbott Laboratories Argentina S.A.
Abbott Rapid Diagnostics
Becton Dickinson Argentina S.R.L.
Bernardo Lew e hijos S.R.L.
BIOARS S.A.
Biocientífica S.A.
Biodiagnostico S.A.
Diagnos Med S.R.L.
I.B Instrumental Bioquímico S.A
Montebio S.R.L.
ONYVA SRL
Roche Diagnostics Argentina
Siemens Healtcare
Tecnolab s.a.
Cromoion SRL
Marcadores Neoplásicos
Abbott Laboratories Argentina S.A.
BIOARS S.A.
Biocientífica S.A.
Biodiagnostico S.A.
Diagnos Med S.R.L.
Siemens Healtcare
Tecnolab s.a.
Cromoion SRL
Micología
Becton Dickinson Argentina S.R.L.
Biodiagnostico S.A.
Parasitología
BIOARS S.A.
Biocientífica S.A.
Biodiagnostico S.A.
ETC Internacional S.A.
Montebio S.R.L.
Tecnolab s.a.
Pediatría y Neonatología
AADEE S.A.
Abbott Rapid Diagnostics
BIOARS S.A.
Biocientífica S.A.
Biodiagnostico S.A.
Diagnos Med S.R.L.
ETC Internacional S.A.
Laboratorios Bacon S.A.I.C.
Montebio S.R.L.
ONYVA SRL
Cromoion SRL
Toxicología y Forense
Abbott Laboratories Argentina S.A.
Abbott Rapid Diagnostics
Biocientífica S.A.
Montebio S.R.L.
Tecnolab s.a.
Cromoion SRL
Virología
Abbott Laboratories Argentina S.A.
Abbott Rapid Diagnostics
Bernardo Lew e hijos S.R.L.
BIOARS S.A.
Biocientífica S.A.
Biodiagnostico S.A.
ETC Internacional S.A.
Montebio S.R.L.
ONYVA SRL
Roche Diagnostics Argentina
Siemens Healtcare
Tecnolab s.a.
Cromoion SRL
Equipamiento e Insumos para Laboratorios
Acreditación de Laboratorios
Biodiagnostico S.A.
Agitadores
BIOARS S.A.
ETC Internacional S.A.
Instrumental Bioquímico S.A.
Aparatos de Medición
BIOARS S.A.
Laboratorios Bacon
Roche Diagnostics Argentina
Bg Analizadores
I.B Instrumental Bioquímico S.A
Autoanalizadores
Abbott Laboratories Argentina S.A.
Abbott Rapid Diagnostics
BIOARS S.A.
Biocientífica S.A.
Biodiagnostico S.A.
B.G Analizadores S.A
JS Medicina Electrónica SRL
I.B Instrumental Bioquímico S.A
Montebio S.R.L.
Roche Diagnostics Argentina
Siemens Healtcare
Bg Analizadores
Balanzas
ETC Internacional S.A.
Centrífugas
ETC Internacional S.A.
Citómetros
Abbott Rapid Diagnostics
Becton Dickinson Argentina S.R.L.
Cromatógrafos
Tecnolab s.a.
Coagulómetro
AADEE S.A.
BIOARS S.A.
Montebio S.R.L.
ONYVA SRL
Bg Analizadores
ECLIA
Roche Diagnostics Argentina
Espectrofotómetros
BIOARS S.A.
Biodiagnostico S.A.
Montebio S.R.L.
Tecnolab s.a.
Gases en sangre y electrolitos
AADEE S.A.
Becton Dickinson Argentina S.R.L.
B.G Analizadores S.A
Gematec S.R.L.
JS Medicina Electrónica SRL
Montebio S.R.L.
Roche Diagnostics Argentina
Siemens Healtcare
Insumos para Laboratorios
AADEE S.A.
Becton Dickinson Argentina S.R.L.
BIOARS S.A.
Biodiagnostico S.A.
Diagnos Med S.R.L.
ETC Internacional S.A.
Gematec S.R.L.
I.B Instrumental Bioquímico S.A
Montebio S.R.L.
Avan Tecnologias IVD
Laboratorio receptor de derivaciones
IACA LABORATORIOS
Laboratorio de Medicina (acreditado bajo Norma ISO 15.189)
MANLAB
Stamboulian Laboratorio (Laboratorio acreditado bajo la norma IRAM-NM-ISO 15189:2010 y el estándar MA2 de la Fundación Bioquímica)
Bg Analizadores
Meganalizar
Laboratorio receptor de derivaciones en Biología Molecular
IACA LABORATORIOS
Laboratorio de Medicina (acreditado bajo Norma ISO 15.189)
MANLAB (Acreditado en Biología Molecular en Fundación Bioquímica Argentina)
Stamboulian Laboratorio (Laboratorio acreditado bajo la norma IRAM-NM-ISO 15189:2010 y el estándar MA2 de la Fundación Bioquímica)
Laboratorio receptor de derivaciones en Inmunología
MANLAB Meganalizar
Stamboulian Laboratorio (Laboratorio acreditado bajo la norma IRAM-NM-ISO 15189:2010 y el estándar MA2 de la Fundación Bioquímica)
Laboratorio receptor de derivaciones en Inmunoserología
IACA LABORATORIOS
Laboratorio de Medicina (acreditado bajo Norma ISO 15.189)
MANLAB Meganalizar
Stamboulian Laboratorio (Laboratorio acreditado bajo la norma IRAM-NM-ISO 15189:2010 y el estándar MA2 de la Fundación Bioquímica)
Laboratorio receptor de derivaciones en Histocompatibilidad e Inmunogenética
MANLAB (Laboratorio habilitado según Resolución Nº 252-253/12 del INCUCAI, para la Tipificación de Receptores y Donantes para Trasplantes de Órganos)
Stamboulian Laboratorio (Laboratorio acreditado bajo la norma IRAM-NM-ISO 15189:2010 y el estándar MA2 de la Fundación Bioquímica)
Laboratorio receptor de derivaciones en Medicina Genómica
MANLAB (Acreditado en Biología Molecular en Fundación Bioquímica Argentina)
Stamboulian Laboratorio (Laboratorio acreditado bajo la norma IRAM-NM-ISO 15189:2010 y el estándar MA2 de la Fundación Bioquímica)
Luminiscencia
Biodiagnostico S.A.
Diagnos Med S.R.L.
Siemens Healtcare
Material Descartable
Becton Dickinson Argentina S.R.L
ETC Internacional S.A.
Montebio S.R.L.
Material de Vidrio
Montebio S.R.L.
Material para Electroforesis
BIOARS S.A.
Biodiagnostico S.A.
ETC Internacional S.A.
Tecnolab s.a.
Biocientífica S.A
Bg Analizadores
MEIA
Abbott Laboratories Argentina S.A.
Micropipetas
B.G Analizadores S.A
ETC Internacional S.A.
Montebio S.R.L.
Tecnolab s.a.
Genómica - Microarrays
Biocientífica S.A.
ETC Internacional S.A.
Quimioliminiscencia
Biodiagnostico S.A.
Montebio S.R.L.
Siemens Healtcare
Tecnolab s.a.
Reactivos
AADEE S.A.
Abbott Laboratories Argentina S.A.
Abbott Rapid Diagnostics
B.G Analizadores S.A
BIOARS S.A.
Biocientífica S.A.
Biodiagnostico S.A.
Diagnos Med S.R.L.
ETC Internacional S.A.
Montebio S.R.L.
I.B Instrumental Bioquímico S.A
Roche Diagnostics Argentina
Siemens Healtcare
Tecnolab s.a.
Cromoion SRL
RIA - IRMA
Diagnos Med S.R.L.
Montebio S.R.L.
Servicio Técnico
Abbott Rapid Diagnostics
BIOARS S.A.
Biodiagnostico S.A.
Instrumental Bioquímico S.A.
Montebio S.R.L.
Tecnolab s.a.
Bg Analizadores
I.B Instrumental Bioquímico S.A
Software
Abbott Laboratories Argentina S.A.
Abbott Rapid Diagnostics
BIOARS S.A.
Diagnos Med S.R.L.
Genetrics S.A. - NextLAB
Termocicladores
Biodiagnostico S.A.
Roche Diagnostics Argentina
GLYM SOFTWARE S.R.L
Avan Tecnologias IVD
Coya Sistemas S.R.L
Test Rápidos
Abbott Laboratories Argentina S.A.
Abbott Rapid Diagnostics
. BG. Analizadores S.A
BIOARS S.A.
Biodiagnostico S.A.
ETC Internacional S.A.
Montebio S.R.L.
Siemens Healtcare
Cromoion SRL
Biocientífica S.A

